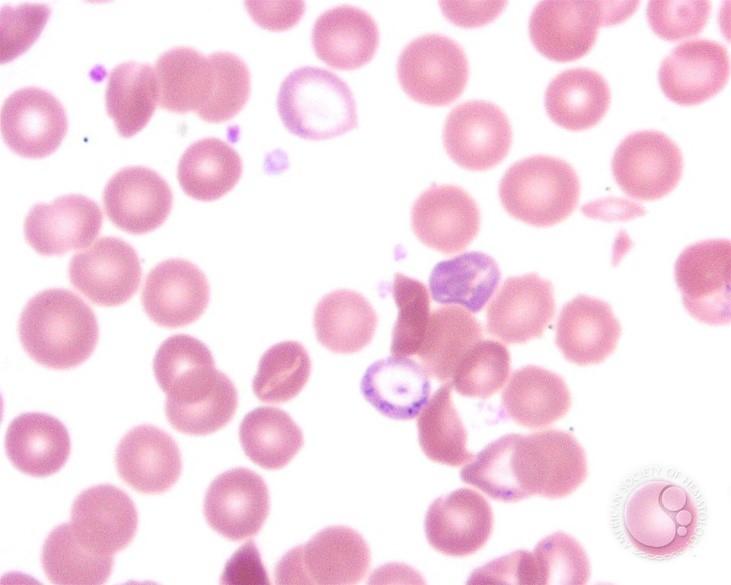

Ιστορικά Στοιχεία / ΑΝΑΔΡΟΜΗ ΚΑΙ ΝΕΟΤΕΡΗ ΕΠΟΧΗ
Αναδρομή…
Το Λαύριο είναι μια μικρή πόλη στο νοτιοανατολικό μέρος της Αττικής και έδρα του Δήμου Λαυρεωτικής. Είναι γνωστό από την κλασική αρχαιότητα για την εξόρυξη ασημιού, που ήταν μια από τις κύριες πηγές εισοδήματος της πόλης-κράτους της Αθήνας, για την παραγωγή νομισμάτων και τη χρηματοδότηση του αθηναϊκού στόλου.
Η ονομασία «Λαύριο» (ή «Λαύρειο», γνωστό κατά τον 19ο αιώνα και ως «Εργαστήρια») προέρχεται από την αρχαία λέξη «λαύρη» ή «λαύρα», που σημαίνει: τη στενωπό, το πέρασμα, τη στοά, τον υπόγειο στενό διάδρομο, τη μεταλλευτική στοά ή τη λιθόστρωτη οδό, και κατά τον Όμηρο: τον διάδρομο, την πάροδο. Στο Λαύριο έχουν αναφερθεί πολλοί αρχαίοι συγγραφείς μεταξύ των οποίων οι: Αισχίνης, Αισχύλος, Αριστοτέλης, Αριστοφάνης, Δημοσθένης, Διόδωρος Σικελιώτης, Θουκυδίδης, Λυσίας, Ξενοφών, Πλίνιος, Πολύαινος, Στράβων, Υπερείδης κ.ά.
Η μεταλλευτική δραστηριότητα στην ευρύτερη περιοχή του Λαυρίου ξεκίνησε πριν το 3.000 π.Χ. σύμφωνα με αρχαιολογικές ενδείξεις. Η εκμετάλλευση των μεταλλείων συνεχίστηκε αδιάπαυστα μέχρι και τον 6ο αιώνα π.Χ. οπότε και αναφέρεται η εντατική και κυρίως η συστηματοποιημένη εκμετάλλευση των αργυρομολυβδούχων μεταλλευμάτων, ενώ ο αρχαίος τρόπος εξόρυξης του μεταλλεύματος πραγματοποιείτο με τη διάνοιξη στοών και φρεάτων. Η επεξεργασία του μεταλλεύματος γινόταν με εμπλουτισμό σε επίπεδα και κυκλικά (ελικοειδή) «πλυντήρια» [π.1] κι έπειτα ακολουθούσε η εκκαμίνευση σε κτιστούς φούρνους. Στοές, πηγάδια, δεξαμενές νερού, φούρνοι, ίχνη από κατοικίες, κοιλώματα και άλλες εγκαταστάσεις σώζονται σε δεκάδες σημεία της Λαυρεωτικής γης και είναι ορατά ακόμη και σήμερα. Το Λαύριο, είναι ένα απ’ τα μεταλλευτικά κέντρα της αρχαίας εποχής και εικάζεται ότι αποτελεί μια απ’ τις αρχαιότερες βιομηχανικές πόλεις της Ευρώπης.


Εκτός από τα μεταλλεία στην περιοχή του Λαυρίου λειτούργησαν και αρχαία λατομεία μαρμάρου από τα οποία εξορύχθηκε υλικό τόσο για τον Ναό του Ποσειδώνα στο Σούνιο, όσο και για το αρχαίο θέατρο του Θορικού. Χτίστηκε γύρω στο 525-480 π.Χ. και έχει σχήμα ελλειπτικό με ορθογώνια ορχήστρα αντί της τυπικής διάταξης σε ημικύκλιο που έχουν τα περισσότερα ελληνικά θέατρα. Θεωρείται ένα από τα αρχαιότερα στο κόσμο και το παλαιότερο σωζόμενο θέατρο στην Ελλάδα. Δημιουργήθηκε για τους εργαζομένους των ορυχείων της περιοχής και υπήρξε σημαντικό κέντρο πολιτιστικής δραστηριότητας.
Στα χρόνια που ακολούθησαν, τα σπλάχνα της Λαυρεωτικής γης σιώπησαν. Τα μάρμαρα του θεάτρου χορτάριασαν, το Λαύριο έγινε ένα μικρό ψαροχώρι και το λαμπρό του παρελθόν ξεχάστηκε. Ελάχιστοι περιηγητές επισκέπτονταν πια τον ναό του Ποσειδώνα στο Σούνιο κι αυτή η άκρη της Αττικής αφέθηκε στη λήθη της ιστορίας.
Νεότερη εποχή…
Η απελευθέρωση της Ελλάδας από τους Τούρκους και η άφιξη των Ευρωπαίων στην χώρα, με απώτερο βέβαια σκοπό την εκμετάλλευσή της, έφερε στο προσκήνιο ξανά τη Λαυρεωτική γη.
Η σύγχρονη μεταλλουργική δραστηριότητα στην περιοχή της Λαυρεωτικής ξεκίνησε το 1864 όταν η εταιρεία γαλλοϊταλικών συμφερόντων Roux-Serpieri-Fressynet & C.E. που ίδρυσε ο Ιταλός επιχειρηματίας Ιωάννης Βαπτιστής Σερπιέρι (Giovanni Battista Serpieri, 1832-1897) εξασφάλισε από την ελληνική πολιτεία το δικαίωμα της εκμετάλλευσης των εκβολάδων [π.2] και της ανακαμίνευσης [π.3] των αρχαίων σκωριών [π.4] που βρίσκονταν διάσπαρτες στην περιοχή.

Η εταιρεία εξαγοράστηκε από την Εταιρεία των Μεταλλουργείων Λαυρίου, γνωστή ως «Ελληνική Εταιρεία» που ίδρυσε ο Ανδρέας Συγγρός το 1873, μετά από συνεννόηση με την ελληνική κυβέρνηση, ώστε να λυθεί μια διαμάχη που προέκυψε μεταξύ του ελληνικού κράτους με τη γαλλοϊταλική εταιρεία, ένα ζήτημα που έμεινε γνωστό ως «Λαυρεωτικά» ή «Λαυρεωτικό Ζήτημα» [π.5].

Τα επόμενα χρόνια δραστηριοποιήθηκαν στην περιοχή κυρίως η «Ελληνική Εταιρεία» και η Γαλλική Εταιρεία Μεταλλείων Λαυρίου (Compagnie Française des Mines du Laurium) γνωστή ως «Γαλλική Εταιρεία» με σκοπό την εξόρυξη μολύβδου, μαγνησίου, καδμίου, ψευδαργύρου και αργύρου.
Έτσι, το σύγχρονο Λαύριο από ξεχασμένο ψαροχώρι, μετετράπη σε μια βιομηχανική πόλη με ραγδαία ανάπτυξη και έγινε προορισμός εσωτερικής και εξωτερικής μετανάστευσης απλών εργατών, εξειδικευμένων εργατοτεχνικών και επιστημόνων (μεταλλειολόγων, μηχανικών, χημικών κ.ά.) που ήρθαν από την Ευρώπη (κυρίως από Ισπανία, Ιταλία, Γαλλία, Αγγλία, Γερμανία), αλλά και από όλες σχεδόν τις άκρες της ηπειρωτικής και νησιωτικής Ελλάδας. Η διαδικασία αυτή συνεχίστηκε κατά τη διάρκεια του 19ου και 20ου αιώνα ενώ, όπως ήταν επόμενο, όλοι αυτοί οι άνθρωποι, έφεραν μαζί τους τα πολιτισμικά χαρακτηριστικά της ιδιαίτερης πατρίδας τους, με αποτέλεσμα τη διαμόρφωση μιας πολυπολιτισμικής κουλτούρας, μιας κοινωνίας που ζούσε αρμονικά, με σεβασμό και αποδοχή της διαφορετικότητας με βάση την εργατική συνείδηση και την αλληλεγγύη.
Το Λαύριο, ως πόλη, άρχισε σταδιακά να διαμορφώνεται γύρω απ’ αυτές τις εταιρίες, «Γαλλική» και «Ελληνική» όπως συνήθιζαν και συνηθίζουν έως σήμερα να τις αποκαλούν οι ντόπιοι. Εργατικές κατοικίες, ιατρείο, νοσοκομείο, φαρμακείο, καταστήματα, αστικός αλλά και υπεραστικός σιδηρόδρομος, ηλεκτροφωτισμός, σχολεία, εκκλησίες ορθόδοξες και καθολικές, δημαρχείο, λιμενικές εγκαταστάσεις ακόμα και προξενεία για την εξυπηρέτηση των ξένων εργαζομένων και βέβαια ο πολιτισμός κι η ψυχαγωγία δε θα μπορούσαν να αποτελούν εξαίρεση. Τα διευθυντικά και ανώτερα στελέχη των εταιριών αυτών, έλληνες και ξένοι, καθώς και τα εξέχοντα πρόσωπα της τοπικής κοινωνίας, ακολουθώντας τα ρεύματα της εποχής στις κοινωνικές συναναστροφές τους, ήταν επόμενο να μιμηθούν την κοσμοπολίτικη ζωή των ευρωπαϊκών πόλεων και της ελληνικής πρωτεύουσας και να υιοθετήσουν την ευρωπαϊκή μουσική ως μέσο ψυχαγωγίας.
Από την άλλη, οι σκληρές συνθήκες της καθημερινής εργασίας των εργατών και εργατοτεχνικών στα έγκατα της γης, στους φούρνους και στις μονάδες εμπλουτισμού στην επιφάνεια, η συχνότητα των εργατικών ατυχημάτων, η μολυβδίαση [π.6] κλπ, συνιστούν κάποιους από τους λόγους που επισπεύδουν τη διαδικασία ανάδυσης στοιχείων συντροφικότητας, συλλογικότητας και αλληλεγγύης ανάμεσα στους εργαζομένους. Ο κατευνασμός και η εκτόνωση επίσης, όλων αυτών των ετερογενών πολιτισμικών ομάδων που ήδη είχαν αρχίσει να διεκδικούν καλύτερες συνθήκες εργασίας και μισθολογικές αυξήσεις ήταν πλέον άμεση ανάγκη. Μια πιθανή εξέγερση των εργαζομένων αιωρούνταν πάντα ως απειλή κάτι που δεν απεφεύχθη τελικά, τον Απρίλη του 1896 [π.7].


Το 1899 μάλιστα, η «Γαλλική Εταιρεία» ολοκλήρωσε τη κατασκευή ενός κτηρίου εκδηλώσεων, όπου στεγάστηκε η μπάντα και γίνονταν τα μαθήματα. Το κτήριο ονομάστηκε κι αυτό «Ευτέρπη» που ήταν μία από τις εννέα μούσες της Ελληνικής μυθολογίας, κόρη του Διός και της Μνημοσύνης και προστάτιδα της Μουσικής. «Ευτέρπη» αποκαλούσαν και τη μπάντα της Φιλαρμονικής Εταιρείας οι Λαυριώτες.
Το νεοκλασικό κτίριο, επιφάνειας 370 τ.μ., ήταν ιδιαίτερης καλαισθησίας εξωτερικά κι εσωτερικά, διακοσμημένο από τον Ιταλό ζωγράφο Adelindo Morelli [π.11] που είχε εγκατασταθεί στο Λαύριο. Χτίστηκε στον Κυπριανό [π.12] κοντά στις εργατικές κατοικίες, με έναν μεγάλο κι όμορφο περιβάλλοντα χώρο δίπλα στο κήπο με τους φοίνικες, γνωστό ως «περιβολάκια». Διέθετε αίθουσα θεάτρου με σκηνή, παρασκήνια και φουαγιέ και συγκέντρωνε ομάδες εργαζομένων, ανεξαρτήτως κοινωνικής ή εργασιακής θέσης, σε διάφορες πολιτιστικές και ψυχαγωγικές εκδηλώσεις, χορούς, ρεσιτάλ, διαλέξεις, θεατρικές παραστάσεις, σχολικές εορτές, κινηματογραφικές προβολές αργότερα κλπ. Εκεί γίνονταν τα μαθήματα μουσικής, οι πρόβες της μπάντας και μαθήματα χορού.
Στο μεταξύ η «Ελληνική Εταιρεία» δε μπορούσε να μείνει αμέτοχη σε αυτή τη πρόκληση κι έτσι, το 1894 δημιούργησε τον «Σύλλογο Φιλομούσων Λαυρίου» [π.13] με στόχο τη διάδοση της μουσικής αλλά και για λόγους αντιπαλότητας με τη «Γαλλική Εταιρεία». Με αρχιμουσικό τον Κωνσταντίνο Γουβέλη (πρώην στρατιωτικό αρχιμουσικό) και με τη συνδρομή του Ιωσήφ Καίσαρη (αρχιμουσικό της Στρατιωτικής Φρουράς Αθηνών) γεννιέται μια άλλη μπάντα που οι ντόπιοι συνήθιζαν να την αποκαλούν «Ορφέα» (Ορφεύς) απ’ τον τραγικό λυριστή-κιθαρωδό της Ελληνικής μυθολογίας. Στεγάστηκε στο κτίριο του «Συλλόγου των Φιλομούσων» (μετέπειτα Πολιτιστικό κέντρο του Δήμου) που η «Ελληνική Εταιρεία» κατασκεύασε γι’ αυτό το σκοπό το 1898 στη πλατεία της πόλης. Το Καταστατικό του Συλλόγου, προέβλεπε την ίδρυση σχολής με δωρεάν δίδακτρα για τη διδασκαλία οργανικής και φωνητικής μουσικής σε μαθητευόμενους, όχι νεότερους των 14 ετών, ούτε μεγαλύτερους των 30 ετών, ενώ το προσωνύμιο της μπάντας «Ορφεύς» δεν έχει καταγραφεί επίσημα στο Καταστατικό ή στο ιδρυτικό ΦΕΚ.

Παρ’ ότι τα συγκεκριμένα σωματεία είχαν συνδρομητικά μέλη, οι μεταλλευτικές – μεταλλουργικές εταιρίες ήταν οι κύριοι χορηγοί. Η «Γαλλική Εταιρεία» στήριζε τη μπάντα της «Ευτέρπης» και η «Ελληνική Εταιρεία» τον «Ορφέα» μέσω του «Συλλόγου των Φιλομούσων», αντίστοιχα. Τους εξασφάλιζαν τους καλύτερους αρχιμουσικούς και μουσικοδιδασκάλους που υπήρχαν στην Ελλάδα τότε, έλληνες ή ξένους (κυρίως Ιταλούς), αναλάμβαναν την αμοιβή τους και τους διέθεταν τα καλύτερα σπίτια στη πόλη για τη διαμονή τους. Τους προμήθευαν τις στολές, το ρεπερτόριο κι όλη την απαραίτητη υλικοτεχνική υποδομή που χρειαζόταν μια μπάντα για να λειτουργήσει, ενώ τα μουσικά όργανα τα προμηθεύονταν μαζικά, κατόπιν παραγγελίας κατευθείαν απ’ την Ιταλική βιοτεχνία κατασκευής ξύλινων και χάλκινων μουσικών οργάνων Romeo Orsi στο Μιλάνο, που δραστηριοποιείτο εκεί, ήδη από το 1870.
Οι «μαθητευόμενοι» ήταν κυρίως νεαροί υπάλληλοι και εργατοτεχνίτες των μεταλλείων και η εκπαίδευσή τους διαρκούσε από τρεις έως έξι μήνες, περιλαμβάνοντας βασική μουσική θεωρία και ρυθμικό σολφέζ με ιταλικούς όρους σε ελληνικούς χαρακτήρες. Στη συνέχεια, ο μαθητευόμενος άρχιζε την εξάσκησή του στο όργανο και μετά από ένα χρόνο περίπου, μπορούσε να συμμετέχει ως «δόκιμος» στις πρόβες της μπάντας. Στο «Σύλλογο Φιλομούσων» οι πρόβες γίνονταν τρεις φορές την εβδομάδα επί μια ώρα, επιπλέον των ωρών εργασίας τους, ενώ στην «Ευτέρπη», οι πρόβες γίνονταν… καθημερινά εκτός Κυριακής και διαρκούσαν από 1,5 έως 3 ώρες επιπλέον των ωρών εργασίας τους. Η διαφορά στις ώρες και στον αριθμό των δοκιμών (πρόβες), οφείλεται στις αντίστοιχες οικονομικές δυνατότητες των μεταλλευτικών εταιρειών. Με τη συμμετοχή του στις πρόβες, ο κάθε μαθητευόμενος λάμβανε ένα επιπλέον ¼ του μισθού που είχε ως εργαζόμενος στην εταιρεία, ενώ ένα επιπλέον ημερομίσθιο λάμβανε αργότερα για κάθε εμφάνιση του με τη μπάντα ως «μουσικός», εφόσον είχε ολοκληρώσει τη μαθητεία του. Αυτά τα επιπλέον χρηματικά ποσά καταβάλλονταν από τις μεταλλευτικές εταιρείες στο τέλος κάθε μήνα μαζί με τον μισθό. Οι εταιρείες φρόντιζαν ακόμα, ώστε «οι μουσικοί τους» να εργάζονται σε ελαφρύτερες εργασίες, όπως σε γραφεία, αποθήκες, εργαστήρια, μηχανουργεία κ.ά.
Έτσι έχουμε ένα ιδιότυπο, ίσως μοναδικό, για τα ελληνικά δεδομένα, εργασιακό καθεστώς ερασιτεχνών μουσικών, όπου πίσω από έναν Μουσικό Σύλλογο και μια Φιλαρμονική Εταιρεία (θεσμοί που άρχισαν να ανθούν σε αναπτυσσόμενες πόλεις ανά την Ελλάδα την εποχή αυτή, κυρίως στα Επτάνησα) «κρύβονταν» ουσιαστικά… δύο μπάντες εργοστασίων που τις στήριζαν οικονομικά.
Όλο αυτό, σε συνδυασμό με το ραγδαία αυξανόμενο επίπεδο των μουσικών, εφόσον η ενασχόλησή τους ήταν σχεδόν καθημερινή ως μέρος της δουλειάς τους, ήταν ένα σημαντικό κίνητρο ώστε όλο και περισσότεροι εργαζόμενοι, κυρίως νεαροί σε ηλικία, να θέλουν να ενταχθούν στις μπάντες αυτές. Ποιός δεν θα ήθελε, άλλωστε, να παίζει μουσική, αντί να στριμώχνεται στις μεταλλευτικές στοές ή να «ψήνεται» εμπρός στους φούρνους τήξεως μολύβδου; Ευνόητα, τα παιδιά των εργαζομένων αλλά και των υπόλοιπων κατοίκων της πόλης, μπορούσαν να μαθητεύσουν κανονικά και να μετέχουν στις μπάντες ως μέλη και βέβαια, όταν έφταναν στην κατάλληλη ηλικία θα μπορούσαν να εργαστούν στις εγκαταστάσεις των εταιρειών, διασφαλίζοντας μια επαγγελματική σιγουριά στο μέλλον.
Με μια πρόχειρη μουσικολογική ματιά, είναι εμφανές πως οι «εταιρείες» θέλησαν να στηρίξουν έμπρακτα τις μπάντες τους παρά το υψηλό κόστος (ειδικά την εποχή αυτή), ακολουθώντας και προωθώντας εφαρμοσμένες τακτικές σε παρόμοιες μεταλλευτικές εταιρείες της Γαλλίας κυρίως, όπου μέσο του πολιτισμού και της ψυχαγωγίας, επιτύγχαναν ομαδοποίηση και συλλογικότητα μεταξύ των εργαζομένων. Κάτι αντίστοιχο με τις περίφημες μπάντες χάλκινων πνευστών της Αγγλίας (brass band), μεταλλευτικών ή μεταλλουργικών κυρίως βιομηχανιών που επιδίδονται σε φεστιβάλ και ετήσιους διαγωνισμούς, δημιουργώντας μια απίστευτη άμιλλα, όσο και προσήλωση μεταξύ των εργαζομένων, ώστε να φέρουν το «πρώτο βραβείο» στη δική τους εταιρεία.
Ο εμπνευστής της «Ευτέρπης» της «Γαλλικής Εταιρείας» του 1893 Νικόλαος Αργυρόπουλος, έχοντας σπουδάσει στη Γαλλία, γνώρισε τους εκεί μουσικούς συλλόγους και τη σχέση τους με τις αντίστοιχες μεταλλευτικές – μεταλλουργικές μονάδες, κυρίως στη περιοχή Limousin της Κεντρικής Γαλλίας και προφανώς προσπάθησε να δημιουργήσει κάτι αντίστοιχο στην Ελλάδα. Ο γιός του Ορέστης Αργυρόπουλος [π.14] στο μεταξύ, μεταλλειολόγος μηχανικός, πιανίστας και συνθέτης, επίσης σπουδαγμένος στη Γαλλία, ήταν εργαζόμενος στην εταιρεία και ο τελευταίος πρόεδρος του Δ.Σ. της «Ευτέρπης» (περίοδο 1924-1930), συνεχίζοντας αμερόληπτα το μουσικο-εκπαιδευτικό σχέδιο του πατέρα του. Η «Ελληνική Εταιρεία» στο μεταξύ… ακολουθούσε πιστά!


Κι αυτό τελικά, βγήκε σε καλό εφόσον η μπάντα της Φιλαρμονικής εταιρείας «Ευτέρπη» της «Γαλλικής Εταιρείας» και η μπάντα του Συλλόγου των Φιλομούσων Λαυρίου «Ορφεύς» της «Ελληνικής Εταιρείας» έθεσαν τα θεμέλια μιας μουσικής παιδείας, παράδοσης και πολιτισμού στο Λαύριο που ελάχιστες πόλεις στη χώρα έχουν ζήσει, ακολουθώντας τον παλμό της πόλης και των κατοίκων της, στις χαρές τους, στις γιορτές τους και στις λύπες τους, συμμετέχοντας σε διάφορες εκδηλώσεις και δίνοντας τακτικές συναυλίες απαιτητικού ρεπερτορίου, κρίνοντας από το ρεπερτόριο που έχει απομείνει.

Αξίζει να αναφέρουμε ότι η μπάντα του Συλλόγου των Φιλόμουσων «Ορφεύς» είχε πάρει μέρος το 1896 στην τελετή έναρξης της πρώτης Ολυμπιάδας [π.15] που έγινε στο Παναθηναϊκό στάδιο στην Αθήνα, γεγονός που μαρτυρά μια δυναμική παρουσία στα δρώμενα της εποχής, ενώ έλαβε το Β’ βραβείο [π.16] για τη συμμετοχή της στην Μεσολυμπιάδα του 1906 [π.17]. Στο Λαύριο, τις υπαίθριες συναυλίες της τις έδινε συνήθως ή στη πλατεία Ηρώων ή στο Νυχτοχώρι (Αισωπίδα), κοντά στο Ναό της Αγίας Παρασκευής, και τον χειμώνα στο θέατρο του «Συλλόγου Φιλομούσων». Το ρεπερτόριο περιλάμβανε συνήθως εμβατήρια, πόλκες, μαζούρκες, βαλς, εισαγωγές, αποσπάσματα από οπερέτες κ.α.

Η φιλαρμονική της «Ευτέρπης», στο μεταξύ, ακολούθησε κι αυτή τη δική της πορεία. Με τις καθημερινές πρόβες, απέκτησε την άνεση να κάνει υπαίθριες συναυλίες με διαφορετικό ρεπερτόριο σχεδόν κάθε εβδομάδα. Έπαιζε κάθε Σάββατο ή Κυριακή στα «περιβολάκια» του Κυπριανού και στο κτήριο της «Ευτέρπης» το χειμώνα. Το ρεπερτόριο περιλάμβανε συνήθως οπερετικές εισαγωγές, αποσπάσματα από όπερες, συμφωνικά έργα κ.α., ειδικά μεταγραμμένα για μπάντα, ενώ το 1900 ή 1901 έλαβε το Β’ Βραβείο σε μουσικούς αγώνες μεταξύ φιλαρμονικών στο Παναθηναϊκό Στάδιο στα πλαίσια των Μεγάλων Γυμναστικών Επιδείξεων των «Πανελλήνιων Αγώνων» που διοργανώνονταν τότε.
Ξακουστοί όμως ήταν και οι χοροί που διοργάνωναν οι μεταλλευτικές εταιρείες ή άλλοι φορείς της πόλης στο κτίριο της «Ευτέρπης» τη περίοδο της Αποκριάς. Από αναφορές σε δημοσιεύματα τύπου της εποχής, προσκλήσεις σε χοροεσπερίδες και προσωπικές μαρτυρίες που πέρασαν από γενιά σε γενιά, μπορούμε να σχηματίσουμε την εικόνα μιας κοσμοπολίτικης προπολεμικής κοινωνίας [π.18] όπου η μουσική, μέσω της φιλαρμονικής της «Ευτέρπης» είχε τον πιο σημαντικό ρόλο στο Λαύριο [π.19 & π.20] και όχι μόνο [π.21].

Φυσικά και οι δύο μπάντες, συμμετείχαν από κοινού σε όλες τις εθνικές και θρησκευτικές εορτές, εξυπηρετώντας συχνά την ευρύτερη περιοχή των Μεσογείων (Κορωπί, Νέα Μάκρη, Σπάτα κ.α.) λόγω έλλειψης φιλαρμονικών εκεί, είτε δίνοντας συναυλίες είτε μετέχοντας σε εθιμοτυπικές υπηρεσίες συμπεριλαμβανομένου και του Πρωτοχρονιάτικου εθίμου της «Διάνας» [π.22].

Τόσος ήταν ο μουσικός πυρετός στο Λαύριο που, το 1931 ιδρύεται ο Καλλιτεχνικός Μουσικός Σύλλογος «Αρίων» [π.23] από τον αρχαίο Έλληνα Κιθαρωδό και Διονυσιακό ποιητή Αρίωνα, που επινόησε τον Διθύραμβο. Αν και λειτούργησε ελάχιστα, η ομώνυμη μπάντα του μουσικού συλλόγου, στελεχώθηκε από δυσαρεστημένους μουσικούς της «Ευτέρπης» και του «Ορφέα». Διαλύθηκε το 1939 και οι μουσικοί του επέστρεψαν στην «Ευτέρπη».
Παράλληλα με τις φιλαρμονικές στο Λαύριο, άρχισε να ανθεί και το χορωδιακό τραγούδι. Στοιχεία ερασιτεχνικών χορωδιακών σχημάτων καταγράφονται ήδη από το 1930, σχεδόν σε κάθε συνοικία της πόλης με τη χορωδία του Κυπριανού να διαθέτει μάλιστα κι όργανα (μαντολινάτα).
Το 1939 επίσης, δημιουργείται η «Χορωδία Λαυρίου», ένα αμιγώς ανδρικό χορωδιακό σύνολο, που άρχισε τη δραστηριότητά του αρχικά ως εκκλησιαστική χορωδία με τη καθοδήγηση του Λαυριώτη μαέστρου Γεώργιου Τζανετάκη (1917-2009), προερχόμενου από μουσική οικογένεια, με πατέρα κι αδελφούς να διατελούν μουσικοί κι αρχιμουσικοί στην «Ευτέρπη».
Αν και η σύσταση επίσημου σωματείου με καταστατικό έγινε μόλις το 1981, η «Χορωδία Λαυρίου» συνέβαλε με τη σειρά της, στα μουσικά δρώμενα της πόλης που αφορούν τη χορωδιακή μουσική, κάτι που συνεχίζει έως τις μέρες μας.

Τέλος εποχής…
Η ζωή της πόλης του Λαυρίου όμως, είναι τόσο στενά συνδεδεμένη με τις βιομηχανίες της περιοχής, που όπως είναι φυσικό ακολούθησε την πορεία τους. Το ίδιο κι οι μπάντες των εταιρειών. Το πρώτο πλήγμα έρχεται με τον Πρώτο Παγκόσμιο Πόλεμο.
Το 1930, η «Ελληνική Εταιρεία» αναγκάζεται να εκποιήσει τις εγκαταστάσεις της. Ήδη από τα τέλη της δεκαετίας του 1920, βρίσκεται αντιμέτωπη με τη συνεχιζόμενη πτώση των τιμών του μολύβδου και τη σταδιακή εξάντληση των κοιτασμάτων, κάτι που επηρέασε βαθιά τη βιωσιμότητα της Ελληνικής μεταλλουργίας. Έτσι ο «Σύλλογος Φιλομούσων Λαυρίου» με τη φιλαρμονική του «Ορφεύς», αναστέλλει σταδιακά τη λειτουργία του, έως ότου διαλυθεί οριστικά το 1920 περίπου!
Η ανεργία από τις εκποιήσεις, αναγκάζει αρκετούς κατοίκους να βρουν σε άλλους τόπους τη τύχη τους, ο πληθυσμός του Λαυρίου μειώνεται αισθητά, ενώ το κτήριο του «Συλλόγου Φιλομούσων» στη πλατεία μετατράπηκε σε σχολείο, αρχικά για τα παιδιά των προσφύγων που ήρθαν στη πόλη το 1922 μετά τη μικρασιατική καταστροφή και έπειτα στέγασε για χρόνια το 2ο Δημοτικό Σχολείο Λαυρίου.
Στο μεταξύ, αρκετοί εναπομείναντες εργαζόμενοι της «Ελληνικής Εταιρείας» βρίσκουν εργασία στη «Γαλλική Εταιρεία» που καταφέρνει να αντέξει επιχειρησιακά τη κρίση της μεταλλουργίας, μετατρέποντας κάποιες εργοστασιακές μονάδες σε ελασματοποιείο για την παραγωγή φύλλων μολύβδου. Έτσι, μουσικοί του «Συλλόγου Φιλομούσων», μαζί με μεγάλο τμήμα του ρεπερτορίου, πηγαίνουν στη φιλαρμονική της «Ευτέρπης» της «Γαλλικής Εταιρείας». Βέβαια, ήδη από το 1913, οι όποιες ευνοϊκές για μουσικούς εργασιακές σχέσεις και οι αμοιβές των μουσικών, αποτελούν πλέον παρελθόν.
Η «Ευτέρπη» στάθηκε πιο τυχερή και κατάφερε να μακροημερεύσει, τουλάχιστο τόσο όσο και η υποστηρίκτριά της «Γαλλική Εταιρεία», μένοντας για 50 χρόνια περίπου, η μοναδική μπάντα στην πόλη μετά το κλείσιμο του «Συλλόγου των Φιλομούσων», συνεχίζοντας να παράγει πολιτισμό και κυρίως μουσική παιδεία στην πόλη του Λαυρίου.

Στο Δεύτερο Παγκόσμιο Πόλεμο, το κτήριο της «Ευτέρπης» επιτάχθηκε από τους Γερμανούς και η φιλαρμονική διέκοψε τη λειτουργία της. Εκεί έγινε το «μπλόκο του Λαυρίου» το 1944 απ’ τις δυνάμεις κατοχής για να συλληφθούν αντιφασίστες πατριώτες. Στα ζοφερά χρόνια του εμφυλίου (1945-1949), χρησιμοποιήθηκε ως έκτακτο στρατοδικείο όπου διαδραματίστηκε και η δίκη του Λαυρίου το 1948 με κατηγορούμενους εξόριστους της Μακρονήσου. Μαρτυρίες λένε, πως τα περίτεχνα ξύλινα αναλόγια της φιλαρμονικής, τα καθίσματα, οι οργανοθήκες και μεγάλο μέρος του ρεπερτορίου, χρησίμευσαν ως προσάναμμα για τις φωτιές που άναβαν οι χωροφύλακες κι οι στρατιώτες φρουροί για να ζεσταθούν τον χειμώνα από το ξεροβόρι του Λαυρίου.
Μετά τον πόλεμο, το κτήριο της «Ευτέρπης» με τη φιλαρμονική της, προσπάθησε να αποκτήσει ξανά το ρόλο και τη θέση που είχε στη ζωή και στην πόλη του Λαυρίου προπολεμικά. Η βοήθεια της «Γαλλικής Εταιρείας» είναι πλέον πενιχρή αλλά το μεράκι και η επιμονή των μουσικών που απέμειναν μεγάλη. Κι έτσι, οι βαριές πόρτες άνοιξαν και πάλι και οι μουσικές δειλά – δειλά ήχησαν ξανά, μια που οι κάτοικοι λαχταρούσαν να γευτούν την ελευθερία τους και να θυμηθούν τα παλιά χρόνια με τους περίφημους χορούς και τις καλοκαιρινές συναυλίες στα «περιβολάκια» του Κυπριανού.
Για σχεδόν 20 χρόνια ακόμα, η «Ευτέρπη» αντέχει, δύσκολα, αλλά αντέχει και συνεχίζει το καλλιτεχνικό και παιδαγωγικό της έργο, με συναυλίες και εμφανίσεις στη πόλη.
Δεν ήταν τυχαίο που ο Νίκος Γκάτσος το 1965 κάνει αναφορά σ’ αυτούς τους χορούς με τους περίφημους στίχους που μελοποιήθηκαν από τον Μάνο Χατζιδάκι κι έγιναν ο ύμνος του Λαυρίου:
«…Κράτησα δίκοπο μαχαίρι στον πικρό καιρό, κι είπα στη νύχτα να σε φέρει και σε καρτερώ. Ποιος είν’ απόψε ο τυχερός; στο Λαύριο γίνεται χορός!» [π.24].

Αλλά η μοίρα είχε άλλα σχέδια, η Φιλαρμονική Εταιρεία «Ευτέρπη» έως το 1960 είχε διακόψει σχεδόν κάθε δραστηριότητα, οι εκδηλώσεις στο ιστορικό κτήριο αραιώνουν σταδιακά ενώ η μπάντα της, από το 1969 κι έπειτα, εμφανίζεται πια σε εθνικές και θρησκευτικές εορτές, μόνο και μόνο απ’ το μεράκι και το πείσμα των μουσικών που επιμένουν δίχως τις στολές τους πια, έως ότου σταματήσουν όλα το 1977.
Βίοι παράλληλοι… η «Γαλλική Εταιρεία» και η «Ευτέρπη» γεννιούνται, ζουν και πεθαίνουν μαζί.
Το 1977, η «Γαλλική Εταιρεία Μεταλλείων Λαυρίου» (ΓΕΜΛ) έχοντας λειτουργήσει για περισσότερο από 100 χρόνια στην περιοχή (1875-1989), διακόπτει τις μεταλλευτικές της δραστηριότητες και εισέρχεται σε μία βαθιά κι οδυνηρή περίοδο κρίσης. Επτά χρόνια αργότερα, μετά από σειρά εσωτερικών αναταραχών και ανεπιτυχών προσπαθειών αναδιοργάνωσης, η Εταιρεία διακόπτει οριστικά και τις μεταλλουργικές τις δραστηριότητες. Οι τεράστιες κτηριακές εγκαταστάσεις αγοράστηκαν από το Ελληνικό Δημόσιο και παραχωρήθηκαν στο τότε Υπουργείο Πολιτισμού που τις κήρυξε στο σύνολο τους διατηρητέο μνημείο. Στη συνέχεια παραχωρήθηκαν στο Εθνικό Μετσόβιο Πολυτεχνείο, το οποίο ίδρυσε το «Τεχνολογικό Πολιτιστικό Πάρκο Λαυρίου» που με τη σειρά του, διαχειρίζεται τη σταδιακή αποκατάσταση των εγκαταστάσεων.

Το κτήριο της «Ευτέρπης», στο μεταξύ, πωλήθηκε σε ιδιώτη και για αρκετά χρόνια χρησίμευσε ως αποθήκη τροφίμων, ενώ το 1981 χαρακτηρίστηκε από το Υπουργείο Πολιτισμού ως ιστορικό, διατηρητέο μνημείο και έργο τέχνης. Τελικά, έπειτα από χρονοβόρες διαδικασίες και δικαστικές διαμάχες, το 2018 αγοράστηκε από τον Δήμο Λαυρεωτικής, ο οποίος στα επόμενα χρόνια (2022-2025) προχώρησε και ολοκλήρωσε την πλήρη αποκατάστασή του.
Παραπομπές
[1]
Τα πλυντήρια ή καθαριστήρια ήταν ειδικές κατασκευές των αρχαίων μεταλλευτών, στις οποίες μεταφέρονταν τα μεταλλεύματα μετά την εξόρυξη, το θρυμματισμό, τη λειοτρίβηση και το κοσκίνισμά τους, για τον περαιτέρω εμπλουτισμό τους, δηλαδή να εξευγενιστούν και εντέλει να αυξηθεί η περιεκτικότητά τους σε χρήσιμες μεταλλικές αξίες.
Η διαδικασία εμπλουτισμού στα πλυντήρια αυτά γινόταν με τη βοήθεια του νερού που έρεε σε ειδικές αυλακώσεις και το θρυμματισμένο μετάλλευμα διαχωρίζονταν σε κόκκους βαρύτερους ή ελαφρύτερους. Οι βαρύτεροι κόκκοι περιείχαν τον πλούσιο αργυρούχο γαληνίτη και αποτελούσαν το «συμπύκνωμα», δηλαδή το πλούσιο σε άργυρο μετάλλευμα, που ακολουθούσε τη διαδικασία της πλινθοποίησης και τήξης (εκκαμίνευσης), ενώ οι ελαφρύτεροι περιείχαν το φτωχό μετάλλευμα, το «απόρριμμα» ή «στείρο», το οποίο απέθεταν σε ξεχωριστούς σωρούς. Αυτό το φτωχό μετάλλευμα δημιούργησε τις γνωστές «εκβολάδες» οι οποίες έγιναν αντικείμενο εκμετάλλευσης κατά την αναβίωση των μεταλλείων στην νεότερη εποχή. Η τροφοδοσία των πλυντηρίων σε νερό για τις ανάγκες του εμπλουτισμού γινόταν μέσω δεξαμενών που βρίσκονται συνήθως παραπλεύρως των πλυντηρίων. Το νερό προερχόταν από τη βροχή και για λόγους οικονομίας γινόταν επανακυκλοφορία αυτού.
Στη Λαυρεωτική γη υπάρχουν δεκάδες ερείπια αρχαίων πλυντηρίων, τα περισσότερα εκ των οποίων ανήκουν στην κατηγορία των επίπεδων. Σπανιότερα είναι τα ονομαζόμενα ελικοειδή.
[2]
Οι εκβολάδες αποτελούν κατάλοιπα της αρχαίας μεταλλευτικής δραστηριότητας στο Λαύριο, τα υπολείμματα δηλαδή από υλικά που εξορύχθηκαν μεν αλλά απορρίφθηκαν απ’ τους αρχαίους μεταλλωρύχους και τα άφηναν στο έδαφος κρίνοντάς τα, μη εκμεταλλεύσιμα λόγω χαμηλής περιεκτικότητας μετάλλου και δε τους συνέφερε οικονομικά να τα επεξεργαστούν, αξιοποιήθηκαν με ειδικούς τρόπους στη μεταλλουργία της βιομηχανικής περιόδου.
[3]
Ανακαμίνευση είναι μια μέθοδος επεξεργασίας των αρχαίων σκωριών (που είχαν ήδη υποστεί εκκαμίνευση) και εφαρμόστηκε στη μεταλλουργία της βιομηχανικής περιόδου στο Λαύριο.

[4]
Σκωρίες είναι τα αρχαία μεταλλουργικά απορρίμματα που παράχθηκαν έπειτα από επεξεργασία μεταλλεύματος. Επρόκειτο για μελανόμορφη βαριά ύλη, κάτι σαν μαύρες πέτρες διαφόρων διαστάσεων, προερχόμενη από την τήξη του μεταλλεύματος, όχι περαιτέρω εκμεταλλεύσιμη με τα δεδομένα της αρχαίας τεχνολογίας, αλλά αξιοποιήσιμη για την μεταλλουργία της βιομηχανικής περιόδου. Αρχαίες σκωρίες καλύπτουν τεράστιες εκτάσεις της Λαυρεωτικής και τμήματα της ακτογραμμής της.
[5]
Ως Λαυρεωτικά ή Λαυρεωτικό ζήτημα περιγράφεται η νομική διαφορά μεταξύ της γαλλοϊταλικής εταιρείας Roux – Serpieri – Fressynet C.E. με το Ελληνικό Δημόσιο σχετικά με την έκταση της εκμετάλλευσης των μεταλλείων του Λαυρίου, διαφορά η οποία απασχόλησε έντονα την κοινή γνώμη την περίοδο 1869-1873.
Συγκεκριμένα το ζήτημα προέκυψε όταν η κυβέρνηση Κουμουνδούρου, ύστερα από πίεση της αντιπολίτευσης και ειδικότερα του Επαμεινώνδα Δεληγεώργη, αμφισβήτησε το δικαίωμα της εταιρείας στην εκμετάλλευση των εκβολάδων, ψηφίζοντας μάλιστα σχετικό νόμο και απαίτησε από την εταιρία καταβολή ενοικίων. Η εταιρεία αρνήθηκε να σταματήσει την εκμετάλλευση και να καταβάλει ενοίκια θεωρώντας ότι δεν ήταν δυνατόν ο νόμος να έχει αναδρομική ισχύ και παράλληλα, ζήτησε την μεσολάβηση των γαλλικών και ιταλικών κυβερνήσεων οι οποίες επενέβησαν υπέρ των συμφερόντων της εταιρείας φυσικά, απαιτώντας αποζημίωση από την Ελληνική κυβέρνηση.
Η απροκάλυπτη συμμετοχή των ξένων δυνάμεων στα εσωτερικά της χώρας προκάλεσε σοβαρή πολιτική κρίση με αποτέλεσμα την δημιουργία πολιτικού κενού λόγω των συχνών παραιτήσεων των κυβερνήσεων (Κουμουνδούρου, Ζαΐμη, Βούλγαρη). Μετά και την αποπομπή της κυβέρνησης Βούλγαρη, πρωθυπουργός διορίστηκε ο Επαμεινώνδας Δεληγεώργης, του οποίου η κυβέρνηση κράτησε σκληρή στάση απέναντι στις ξένες κυβερνήσεις, οι οποίες επέμεναν απειλώντας πως ετοιμάζονται να στείλουν κανονιοφόρους στο Σούνιο. Μπροστά στο αδιέξοδο, ο πρωθυπουργός και ο βασιλιάς Γεώργιος Α’, ο οποίος διαδραμάτιζε παρασκηνιακό ρόλο σε όλη τη διάρκεια των διαπραγματεύσεων, απευθύνθηκαν στον ομογενή τραπεζίτη Ανδρέα Συγγρό που είχε εγκατασταθεί στην Αθήνα προερχόμενος από την Κωνσταντινούπολη. Ο τελευταίος, ως πληρεξούσιος της Τράπεζας Κωνσταντινουπόλεως, κατόρθωσε να έρθει σε συμφωνία με την γαλλοιταλική εταιρία και τον Φεβρουάριο του 1873 υπογράφηκε συμφωνία μεταβίβασης των μεταλλείων σε νεοσυσταθείσα εταιρεία με την επωνυμία «Ελληνική Εταιρεία Μεταλλουργείων Λαυρίου».

Σχεδόν αμέσως η εταιρεία εξέδωσε μετοχές ονομαστικής αξίας 200 φράγκων. Η φημολογία γύρω από τα δήθεν τεράστια αποθέματα του Λαυρίου καθώς και η στήριξη των τραπεζών προς την εταιρεία οδήγησαν χιλιάδες Έλληνες, απ’ όλες τις οικονομικές τάξεις, στην αγορά μετοχών εκτοξεύοντας συνεχώς την τιμή τους. Με την πάροδο του χρόνου οι προσδοκίες εξαντλήθηκαν με συνέπεια η τιμή της μετοχής να καταγράψει ραγδαία πτώση (σχεδόν 70%). Η πτώση αυτή είχε σαν αποτέλεσμα τον διπλασιασμό των πτωχεύσεων και τον εξανεμισμό των μικροαποταμιεύσεων, χαρακτηρίζεται δε, ως η μεγαλύτερη μεταφορά κεφαλαίου στην Ελλάδα από τις κατώτερες τάξεις στις ανώτερες.
Την δραματική οικονομική καταστροφή χιλιάδων οικογενειών ακολούθησε η παραίτηση του Επαμεινώνδα Δεληγεώργη στις αρχές Φεβρουαρίου 1874, ο οποίος θεωρήθηκε υπεύθυνος για την εξέλιξη. Πρόκειται για το πρώτο χρηματιστηριακό σκάνδαλο στην ελληνική ιστορία.
[6]
Η Μολυβδίαση είναι η χρόνια δηλητηρίαση από μόλυβδο και είναι ιστορικά η πρώτη επαγγελματική ασθένεια που καταγράφηκε και αναγνωρίστηκε. Ο μόλυβδος είναι ένα ιδιαίτερα τοξικό μέταλλο για τον άνθρωπο, ειδικά στα στάδια της επεξεργασίας του. Οι μεταλλουργοί κι όσοι έρχονται σε καθημερινή επαφή μαζί του είναι ιδιαίτερα ευάλωτοι, όπως και τα παιδιά που μεγαλώνουν ζώντας σε μολυσμένο από μόλυβδο ή παράγωγά του, περιβάλλον.
Η χρόνια λήψη ή εισπνοή μόλυβδου, προκαλεί σταδιακά τη καταστροφή του κεντρικού και περιφερικού νευρικού συστήματος, των νεφρών, των αιμοποιητικών οργάνων και του γαστρεντερικού συστήματος. Τα πρώιμα συμπτώματα περιλαμβάνουν απώλεια όρεξης, απώλεια βάρους, αναιμία, έμετο, κόπωση, αδυναμία, κεφαλαλγία, την ύπαρξη κυανής γραμμής στα ούλα, απάθεια ή ευερεθιστότητα και την χαρακτηριστική μεταλλική γεύση στο στόμα. Αργότερα αναπτύσσονται συμπτώματα παράλυσης, απώλεια της αισθητικότητας, απώλεια του συντονισμού, ασαφή άλγη και εγκεφαλοπάθεια.

Η εργαστηριακή διάγνωση γίνεται διαμέσου της αναιμίας, των επιπέδων μόλυβδου στο αίμα (πάνω από 5 mcg/dl), της αύξησης της ελεύθερης πρωτοπορφυρίνης των ερυθροκυττάρων, της αυξημένης αποβολής μόλυβδου στα ούρα ή των χαρακτηριστικών ακτινογραφικών αλλαγών στα άκρα των αναπτυσσόμενων οστών των παιδιών.
Χαρακτηριστική είναι η φωτογράφιση μέσο μικροσκοπίου, των ερυθρών αιμοσφαιρίων με τις χαρακτηριστικές σκούρες (μελανόμορφες) κηλίδες (βασεόφιλη στίξη) που υποδηλώνει αναιμία λόγω μολύβδου, όπως δημοσιεύτηκε στη βάση δεδομένων της American Society of Hematology (ASH Image Bank).
Η θεραπεία στην εποχή μας είναι εφικτή αν διαγνωστεί έγκαιρα η μόλυνση και απαιτεί ισχυρή φαρμακευτική αγωγή και άμεση απομάκρυνση από την μολυσματική εστία, κυρίως των παιδιών μια που η απορρόφηση του προσλαμβανόμενου μολύβδου σ αυτά, μπορεί να φτάσει το 40-50% σε σχέση με τους ενήλικες που απορροφούν ένα 10%. Σε προχωρημένο όμως στάδιο (πάνω από 45 mcg/dl), οι πολυοργανικές βλάβες που επιφέρει είναι μη αναστρέψιμες.
[7]
1896! Οι συνθήκες εργασίας που επικρατούσαν στα μεταλλεία του Λαυρίου ήταν τραγικές. Εργάτες σκοτώνονταν κατά τις ανατινάξεις εξόρυξης (φουρνέλα), ενώ άλλοι πέθαιναν βασανιστικά από μολυβδίαση μια που το κοίτασμα του Λαυρίου περιείχε αργυρούχο μόλυβδο, ιδιαίτερα τοξικό για τον άνθρωπο. Ο χρόνος εργασίας έφτανε τις 12 ώρες, με νυχτερινή εργασία στις καμίνους ενώ ο μέσος όρος ζωής στα ορυχεία έφτανε τα 21,5 χρόνια και το 1906 τα 18,5 χρόνια. Παράλληλα, η μέριμνα για άμεση φροντίδα τραυματισμένων εργατών από την εργοδοσία ήταν τόσο ανύπαρκτη, που συχνά πέθαιναν κατά τη μεταφορά τους στο νοσοκομείο η οποία γινόταν με κάρο. Γι’ αυτό ζητούσαν το αυτονόητο, σε πρώτη φάση αφενός να μεταφέρονται έγκαιρα και με ασφάλεια, καθώς επίσης και να δημιουργηθεί χώρος νοσηλείας πιο κοντά στις μεταλλευτικές στοές. Οι «εργολάβοι» της εποχής, στο μεταξύ, είχαν μια αναλογία με τις σημερινές «εργολαβίες». Ήταν, δηλαδή, μεσάζοντες στους οποίους η εταιρεία ανέθετε το έργο κάποιας στοάς και έβαζαν εργάτες να δουλεύουν για τους ίδιους. Χωρίς να αποτελούν εξαίρεση στον κανόνα, οι εργολάβοι έπαιρναν από την εταιρεία αρκετά χρήματα για να καλύψουν, υποτίθεται, τα μεροκάματα των εργατών, ωστόσο αυτοί τελικά έδιναν μόνο μερικά «ψίχουλα» στους μεταλλωρύχους, τσεπώνοντας οι ίδιοι το μεγαλύτερο μέρος.

Έτσι, τα ξημερώματα της 8ης Απριλίου του 1896, περίπου 1.800 μεταλλωρύχοι που εργάζονταν στην Καμάριζα (κοινότητα Αγίου Κωνσταντίνου), ανεβαίνουν από τα έγκατα των ορυχείων, κλείνουν τις εισόδους των μεταλλευτικών στοών, περικυκλώνουν τον χώρο και προχωρούν σε απεργία. Η αρχική επιδίωξη των εργατών ήταν να διαπραγματευτούν με τη Διεύθυνση διεκδικώντας ιατροφαρμακευτική περίθαλψη, αυξήσεις στο μισθό τους και απομάκρυνση των εργολάβων. Ωστόσο, όταν έφτασαν έξω από τα γραφεία της Γαλλικής Εταιρείας οι φύλακες πυροβόλησαν προς το μέρος των απεργών, με τους μεταλλωρύχους να απαντούν λιθοβολώντας τους φύλακες και ο χώρος των ορυχείων να μετατρέπεται σε πεδίο μάχης. Στις πρώτες αυτές συγκρούσεις δύο εργάτες έπεσαν νεκροί από τα πυρά των φυλάκων, αυτή η εξέλιξη εξόργισε τους απεργούς οι οποίοι επιτέθηκαν στα γραφεία της εταιρείας, σπάζοντάς τα και βάζοντας φωτιά στο κτήριο, χρησιμοποιώντας μέχρι και δυναμίτη. Από την επίθεση σκοτώθηκαν δύο φύλακες ενώ με τη μεσολάβηση του τότε Δημάρχου Λαυρίου Φωκίωνα Νέγρη στον Φερδινάνδο Σερπιέρη, διευθυντή της εταιρίας τότε, αποφεύχθηκαν τα χειρότερα.
Ο Φερδινάνδος (Φερνάνδος) Σερπιέρης (περί του 1858 – 1927) ήταν Έλληνας επιχειρηματίας και βιομήχανος, γιος του Ιωάννη Βαπτιστή Σερπιέρη, που συνέχισε και επέκτεινε τις μεταλλευτικές και μεταλλουργικές δραστηριότητες της οικογένειας στο Λαύριο. Διετέλεσε πρόεδρος της επιτροπής των Ολυμπιακών Αγώνων του 1896, ήταν ιδρυτής και πρώτος πρόεδρος της Ένωσης Μεταλλευτικών Επιχειρήσεων και είχε σημαντική δράση στον αθλητισμό, ειδικά στην ιππασία.
Η απεργία συνεχίστηκε αρκετές ημέρες ακόμα, με το κράτος να κινητοποιεί αστυνομία και στρατό εναντίον των απεργών· έστειλαν μέχρι και πολεμικό πλοίο για να καταστείλουν και να τρομοκρατήσουν τους μεταλλωρύχους! Η επέμβαση του στρατού οδήγησε σε νέες συμπλοκές τις ημέρες που ακολούθησαν. Ακόμα δύο εργάτες σκοτώθηκαν στις συγκρούσεις, πολλοί περισσότεροι τραυματίστηκαν, 15 απεργοί συνελήφθησαν και οδηγήθηκαν σε δίκη ενώ υπήρχαν εντάλματα σύλληψης για άλλους δέκα, αλλά πρόλαβαν και έφυγαν. Έτσι… έληξε βίαια η απεργία. Το μόνο που πέτυχαν οι εργάτες ήταν μια μικρή αύξηση του μεροκάματου από 2.5 δραχμές σε 3.5 (αύξηση 40%) ενώ όλα τα υπόλοιπα αιτήματα ξεχάστηκαν από την εργοδοσία.
Μετά την εξέγερση των μεταλλωρύχων του Λαυρίου, εγκαταστάθηκε κοντά στα μεταλλεία στρατιωτική δύναμη σε μόνιμη βάση, με στόχο την αποτροπή νέων εξεγέρσεων, αναγκάζοντας τους εργάτες να δουλεύουν κάτω από ένα καθεστώς πραγματικής στρατιωτικής τρομοκρατίας. Ακόμα σώζονται τα ερείπια του στρατώνα στην Καμάριζα!
Αξίζει να σημειωθεί πως είχε προηγηθεί εξέγερση των μεταλλωρύχων το 1873, ως αντίδραση τους στο «Λαυρεωτικό ζήτημα» ενώ, σημαντικές εργατικές κινητοποιήσεις έγιναν μεταγενέστερα με αποτέλεσμα το Λαύριο να πρωτοστατεί, στους αγώνες της εργατικής τάξης. Το 1929, μια απεργία που κράτησε 47 ολόκληρες μέρες με έναν δολοφονημένο μεταλλωρύχο απ’ τις δυνάμεις καταστολής, ανάγκασε τον Ελευθέριο Βενιζέλο να επισκεφτεί το Λαύριο και να υποσχεθεί στους απεργούς πως θα τους δώσει γη, επειδή δεν μπορεί να παρέμβει στη «Γαλλική Εταιρεία» για να αυξηθούν οι μισθοί τους. Το 1950 έγινε μια ακόμη μεγάλη απεργία που κράτησε 29 μέρες με τους εργάτες να πετυχαίνουν το διπλασιασμό του ημερομίσθιου και καλύτερες συνθήκες εργασίας. Το 1959 η εταιρεία μειώνει το προσωπικό και οι εργάτες προχωρούν σε απεργία πείνας μέσα στις μεταλλευτικές στοές. Μετά από 10 ημέρες τα αιτήματά τους γίνονται αποδεκτά από την εργοδοσία ενώ το 1961, γίνεται η τελευταία μεγάλη απεργία των μεταλλωρύχων. Κρατά σχεδόν 72 μέρες και τα αιτήματα είναι πάλι οικονομικά.
[8]
Στη μελέτη – κατάλογο της Compagnie française des mines du Laurium αναρτημένη στο διαδίκτυo [www.entreprises-coloniales.fr/], ως διευθυντής/αρχιμηχανικός (ingénieur principal) της Γαλλικής Εταιρείας Μεταλλείων Λαυρίου στις αρχές της δεκαετίας του 1890 ήταν ο Jean-Marie-Eugène Mercier-Pageyral (περίοδο 1890-1897), ενώ σύγχρονες ελληνικές μελέτες για το Λαύριο αναφέρουν ονόματα όπως de Catelin, Collet, Schulte κ.ά. ως μηχανικούς – διευθυντές τμημάτων. Απ’ τις ίδιες πηγές πληροφορούμαστε πως πρόεδρος (président du conseil) της «ανώνυμης εταιρίας» (société anonyme) Compagnie française des mines du Laurium κατά τη Γενική Συνέλευση της 17 Ιουνίου 1893 ήταν ο Achille Monchicourt. Ως βασικοί μέτοχοι εμφανίζονται οι Jean-Baptiste (Giambattista) Serpieri, Léonard Mercati και Χρήστος Αντωνόπουλος, ενώ σημαντικός χρηματοδότης υπήρξε ο Hilarion-Julien Roux.
Από το ιδρυτικό ΦΕΚ της «Φιλαρμονικής εταιρίας Ευτέρπη» υπ. αριθμόν 224 Α 29/11/1893 σελ. 959 κεφ. Α’ πληροφορούμαστε πως το πρώτο Διοικητικό συμβούλιο απετέλεσαν οι κ.κ.: Νικόλαος Αργυρόπουλος – ιατρός και πρόεδρος του Δημοτικού Συμβουλίου, Ιούλιος Μπαμπέ – μηχανικός της Γαλλικής μεταλλευτικής εταιρίας, Τίτος Βουργίνης – εμποροϋπάλληλος, Ανδρέας Κοσκινάς – δικηγόρος και Α’ δημαρχικός πάρεδρος, Ανδριανός Κολλέ – μηχανικός, Αντώνιος Γονίδης – έμπορος, Αλφρέδος Τζιάνη – υπάλληλος, Ιωσήφ Σιούλτε – μηχανικός των εργοστασίων της Γαλλικής εταιρίας, Γαστών Βαλαντέν – μηχανικός του μηχανουργείου της ίδιας εταιρίας, Μήλιος Βλάσης – έμπορος και Β’ δημαρχικός πάρεδρος και τέλος, ο Παναγιώτης Δαμουκάρης – έμπορος.

[9]
Η Φιλαρμονική Εταιρεία «Ευτέρπη» συστάθηκε στης 29/11/1893, το καταστατικό κατατέθηκε στον συμβολαιογράφο Λαυρίου Κων. Καραμανίδη με την υπ’ αριθ. 17704 πράξη και εγκρίθηκε με ΦΕΚ 224 Α 29/11/1893. Οι ημερομηνίες συστάσεως ακολουθούν την τυπική γραφειοκρατική διαδικασία, προφανώς η μπάντα του συλλόγου είχε ξεκινήσει να λειτουργεί εκπαιδεύοντας τους μουσικούς της τουλάχιστον 4 με 5 έτη πριν.
Διοικούταν από Δ.Σ. (αιρετό Διοικητικό Συμβούλιο) ενώ κύριος χρηματοδότης ήταν η Γαλλική Εταιρεία Μεταλλείων Λαυρίου (Compagnie Française des Mines du Laurium) γνωστότερη κι ως «Γαλλική Εταιρεία» και η συνδρομή των μελών. Στεγάστηκε στο ιδιόκτητο νεοκλασικό κτήριο «Ευτέρπη» της «Γαλλικής Εταιρείας» που αποπερατώθηκε το 1899 γι’ αυτό το σκοπό.
Αρχιμουσικοί διετέλεσαν:
1893 – 1900: Fransesco Nicolini (Ιταλός)
1900 – 1902: Λεωνίδας Ραφαέλοβιτς
1902 – 1903: Βενέδικτος Μνιαγιώνης
1903 – ;: (;) Passarο (Ιταλός), ανασύσταση της Φιλαρμονικής εταιρείας
; – ;: Michael Mangel (Αυστριακός), της οικογένειας Στρατιωτικών Αρχ/κων Μάγγελ
; – ;: Antonio Biferno (Ιταλικής καταγωγής), πατέρας του Αρχ/κου Σπυρίδωνα Μπιφέρνο
1908 – ;: Nicola Martino (Ιταλός), διατέλεσε και ως βοηθός μαέστρος και ως μεταγραφέας
; – 1910: (;) Muguaguoni (Ιταλός)
1911 – 1912: Corrado Caradori ή Carradori (Ιταλός)
1912 – 1920: Νικόλαος Γκίνος
1920 – 1922: Μιχάλης Μάστορας, πατέρας του Στάθη Μάστορα, συνθέτη φημισμένων οπερετών
1922 – 1924: Νικόλαος Ζάρμπ, μαθητής του Corrado Caradori και του Νικόλαου Γκίνου
1924 – 1927: Νικόλαος Γκίνος
1927 – 1928: Tony Schultze (Ολλανδός), δάσκαλος βιολιού, στα πλαίσια μιας προσπάθειας σύστασης σχολής εγχόρδων οργάνων
1928 – 1931: Διακοπή λειτουργείας λόγω οικονομικών δυσκολιών της «Γαλλικής Εταιρείας»
1931 – 1933: Νικόλαος Ζάρμπ, ανασύνθεση μπάντας και ίδρυση σχολής εγχόρδων οργάνων
1933 – 1940: Μιχάλης Τζανετάκης, μαθητής του Νικόλαου Ζάρμπ
1940 – 1945: Διακοπή λειτουργίας λόγω Γερμανικής κατοχής και εμφυλίου
1945 – 1946: Μιχάλης Τζανετάκης & Νικόλαος Ζάρμπ, σταδιακή ανασύσταση της μπάντας
1946 – 1955: Νικόλαος Ζάρμπ
1955 – 1969: Κωνσταντίνος Ρούσσος, ενώ από το 1960 περίπου η καλλιτεχνική δραστηριότητα της φιλαρμονικής περιορίζεται σταδιακά ακολουθώντας τη μοίρα της «Γαλλικής Εταιρείας». Καθήκοντα αρχιμουσικού, μετά τον αιφνίδιο θάνατο του Κωνσταντίνου Ρούσσου στις 8/5/1969, διατελούσαν, περιστασιακά, μουσικοί της φιλαρμονικής με βάση την μουσική τους επάρκεια και την αρχαιότητα. Οι εμφανίσεις της σταδιακά περιορίστηκαν μόνο στις εθιμοτυπικές, ενώ οι μουσικοί, απορροφήθηκαν από την Δημοτική Φιλαρμονική που δημιουργήθηκε στο μεταξύ υπό τη διεύθυνση του Νικόλαου Ζάρμπ. Το 1977 η «Φιλαρμονική Εταιρεία Ευτέρπη» όπως και η «Γαλλική Εταιρεία» διακόπτει οριστικά κάθε δραστηριότητα, μετά από ουσιαστική παρουσία 70 και πλέον ετών. Θα πρέπει να σημειωθεί επίσης ότι, από το 1913 και έπειτα, οι μουσικοί δεν ελάμβαναν καμία αποζημίωση για τις υπηρεσίες τους και οποιαδήποτε καλλιτεχνική ή εκπαιδευτική δραστηριότητα γίνονταν εθελοντικά.
Διακρίσεις:
Συμμετοχή σε διαγωνισμό φιλαρμονικών στο Παναθηναϊκό Στάδιο το 1900 ή 1901 στα πλαίσια των «Σχολικών και Γυμναστικών αγώνων» που διοργανώνονταν τότε, στους οποίους έλαβε το Β’ Βραβείο.
[10]
Μπάντα – Ιταλ.: Banda, Αγγλ.: Band, Κατά Σπύρο Μοντσενίγο «Νεοελληνική μουσική», Κεφ. Α’ σελ. 19-43, [Αθήνα 1958] είναι λέξη αρχαίας Γοτθικής προέλευσης και όχι Ιταλικής όπως λανθασμένα επικρατή, που εξ αρχής προσδιόριζε την ομάδα των μουσικών που ρύθμιζαν το βήμα των στρατιωτών κατά τη πορεία και τους εμψύχωναν κατά την ώρα της μάχης. Η λέξη «μπάντα» σταδιακά κυριάρχησε σε όλες τις γλώσσες και μ’ αυτήν, χαρακτηρίζονται πλέον οι ορχήστρες πνευστών και κρουστών οργάνων. Το χαρακτηριστικό της μπάντας είναι πως εκτός των άλλων, μπορεί να παίζει (παιανίζει) βαδίζοντας και μάλιστα σε παράταξη.
Παλαιότερα η λέξη «μπάντα» χαρακτήριζε τη… συμμορία, ενώ στην Ελλάδα η πρώτη επαφή του απλού κόσμου με τη λόγια Δυτική μουσική και τη πολυφωνία ξεκίνησε περί του 1833, πολύ αργότερα απ’ την υπόλοιπη Ευρώπη, και συνδέθηκε άμεσα με τις στρατιωτικές ορχήστρες πνευστών (μπάντες) ενώ αργότερα, δημιουργήθηκαν σταδιακά οι πρώτες ιδιωτικές Φιλαρμονικές Εταιρείες (με την έννοια της Εταιρείας των Φίλων της Αρμονίας = Φιλαρμονική) και Όμιλοι ή Σύλλογοι Φιλομούσων κ.ά., αναλαμβάνοντας ουσιαστικά σημαντικό μουσικοπαιδαγωγικό έργο σε όλη την επικράτεια, αναπληρώνοντας την παντελή απουσία του κράτους.
Επειδή, όλοι αυτοί οι φορείς (εταιρίες, σύλλογοι, σωματεία κλπ) διατηρούσαν στο δυναμικό τους μια μπάντα, κυρίως ως αποτέλεσμα του μουσικοπαιδαγωγικού τους έργου, η λέξη «φιλαρμονική» ως προσωνύμιο του ιδιωτικού εταιρικού φορέα, αφορούσε άμεσα σε αυτές. Έτσι στην Ελλάδα (και μόνο) όταν χρησιμοποιούμε τη λέξη «φιλαρμονική» εννοούμε τη «μπάντα».

[11]
Όπως μας πληροφορεί ο συμπολίτης μας Αριστείδης Γ. Κανατούρης στην μελέτη του «Η προξενική εκπροσώπηση στο Λαύριο, 1874-1940», ο ζωγράφος Adolindo Morelli (1844-1909) ήλθε στην Ελλάδα προσκεκλημένος από τον Ιωάννη Βαπτιστή Σερπιέρη, του οποίου υπήρξε διακοσμητής. Ο A. Morelli διακόσμησε στο Λαύριο τον Καθολικό Ναό της Αγίας Βαρβάρας, την οροφογραφία της αίθουσας της Φιλαρμονικής «Ευτέρπη», καθώς και οροφογραφίες άλλων κτηρίων. Στην Αθήνα συμμετείχε στην διακόσμηση του Μεγάρου Σερπιέρη (μετέπειτα μέγαρο της Αγροτικής Τράπεζας) επί της οδού Πανεπιστημίου. Από δημοσιεύματα του τύπου πληροφορούμαστε ότι είχε αναλάβει την διακόσμηση του Ναού της Αγίας Βαρβάρας στο Λαύριο κατά την τέλεση του μνημοσύνου για τον βασιλέα Ουμβέρτο της Ιταλίας την 15η Αυγούστου 1900. Ο A. Morelli πέθανε στο Λαύριο στις 19 Δεκεμβρίου 1909 και τάφηκε στο Δημοτικό Κοιμητήριο Λαυρίου.
Ο γιός του, Orfeo Morelli (1874 – 1945), σπούδασε Οικονομικά στο Πανεπιστήμιο της Πίζας και μετά την αποφοίτησή του, προσελήφθη την 1η Νοεμβρίου 1894 ως λογιστής στη Γαλλική Εταιρεία Μεταλλείων Λαυρίου (Γ.Ε.Μ.Λ.), στην οποία και εξελίχθηκε ως Αρχιλογιστής το 1915 και αργότερα ως Οικονομικός και Διοικητικός Διευθυντής. Παράλληλα με την εργασία του στη Γ.Ε.Μ.Λ., προσέφερε τις υπηρεσίες του ως εκλεγμένος Πρόεδρος από το 1916 του Τμήματος Λαυρίου της Ιταλικής Εταιρείας Αλληλοβοήθειας και Αγαθοεργίας στην Αττική. Διετέλεσε γραμματέας (chancelier) του Βελγικού Υποπροξενείου στο Λαύριο, ενώ προκύπτει ότι παρόμοια υπηρεσία είχε αναλάβει και στο Προξενικό Πρακτορείο της Ιταλίας. Το 1939 ανέλαβε την θέση του Προξενικού Πράκτορος της Ιταλίας στο Λαύριο. Αξιομνημόνευτη είναι και η συνδρομή του στην, με κάθε μυστικότητα και με κίνδυνο της ζωής όσων συμμετείχαν, παραγωγή αργύρου στη Γ.Ε.Μ.Λ. κατά τη διάρκεια της κατοχής, με σκοπό την πώλησή του για τη χρηματοδότηση συσσιτίων. Η ριψοκίνδυνη αυτή επιχείρηση έγινε με πρωτεργάτη τον τότε αρχιμηχανικό της Γ.Ε.Μ.Λ. Κωνσταντίνο Κονοφάγο με συνεργάτες εχέμυθους εργαζόμενους και με τη συγκατάθεση του Γενικού Διευθυντή της Γ.Ε.Μ.Λ., Βέλγου Maurice Bremmer, κυριολεκτικά κάτω από τη μύτη της Ιταλικής διοίκησης της Εταιρείας. Ο Orfeo Morelli ήταν θείος της Ευγενίας Βακαλοπούλου, συζύγου του Κ. Κονοφάγου, και ως Οικονομικός Διευθυντής της Γ.Ε.Μ.Λ. παρουσίαζε εικονικά λογιστικά στοιχεία στους κατακτητές, ενώ με άκρα μυστικότητα κρατούσε τα αναγκαία διπλά λογιστικά βιβλία για να αποδοθεί λογαριασμός στην εταιρεία μετά τον πόλεμο, όπως και έγινε όταν η ιδιοκτήτρια εταιρεία Penarroya ζήτησε λογαριασμό.

[12]
Ο «Κυπριανός» είναι μια απ’ τις συνοικίες που αποτελούν την πόλη του Λαυρίου, οι περισσότερες εκ των οποίων υπάρχουν από πολύ παλιά. Σύμφωνα με το βιβλίο του Ευάγγελου Κακαβογιάννη «Επιλογή τοπωνύμιων Λαυρεωτικής» (εκδ. Ε.ΜΕ.Λ. 1986), η ονομασία τους προέρχεται συνήθως από την γεωγραφική προέλευση των ανθρώπων που έχτισαν τα σπίτια τους εκεί κατά τη περίοδο της εκβιομηχανοποίησης της πόλης ή αφορούν μεγάλες περιοχές, που δηλώνουν την ύπαρξη μεταλλεύματος κατά την αρχαιότητα ή εργοστασίων μεταγενέστερα. Χαρακτηριστικό σημείο του Κυπριανού είναι τα «περιβολάκια» ή «ο κήπος με τους φοίνικες» ή «φοινικόδασος» που επικρατεί στην εποχή μας. Ο Κυπριανός, αποτελεί τον πρώτο αμιγή εργατικό οικισμό στην Ελλάδα από τον 19ο αιώνα, χαρακτηριστικής αρχιτεκτονικής.
Σύμφωνα με τον Δήμο Λαυρεωτικής, οι κύριες συνοικίες της Λαυρεωτικής είναι: Θορικό (παλαιό και νέο), Καβοδόκανος, Κυπριανός (παλαιός και νέος), Σπανιόλικα (επίσης εργατική συνοικία), Σαντορινέϊκα ή Θηραϊκά, Πράσινη Αλεπού, Αγ. Παρασκευή, Νυκτοχώρι (Αισωπίδα), Νεάπολη (παλιά Μανιάτικα), Ρουμάνικα, Συνοικισμός, Εργατικές κατοικίες, κ.ά. και οι κύριοι οικισμοί: Πάνορμος, Πουνταζέζα, Κάτω Ποσειδωνία (Λιμάνι Πασσά), Αγ. Γεράσιμος, Αγριλέζα, Κάτω Σούνιον, Λεγραινά, Αγ. Ανδρέας, η κοινότητα του Αγ. Κωνσταντίνου (Καμάριζα) κ.ά.

[13]
Ο «Σύλλογος Φιλομούσων Λαυρίου» συστάθηκε στις 14/12/1894, το καταστατικό κατατέθηκε στον συμβολαιογράφο Λαυρίου Κων. Καραμανίδη με την υπ’ αριθ. 18872 πράξη και εγκρίθηκε με Β.Δ. (Βασιλικό διάταγμα) στις 25/1/1895 – ΦΕΚ 18 Γ 17/2/1895. Οι ημερομηνίες συστάσεως ακολουθούν την τυπική γραφειοκρατική διαδικασία, προφανώς η μπάντα του συλλόγου είχε ξεκινήσει να λειτουργεί εκπαιδεύοντας τους μουσικούς της τουλάχιστον 4 με 5 έτη πριν.
Διοικούταν από Δ.Σ. (αιρετό Διοικητικό Συμβούλιο) ενώ κύριοι χρηματοδότες ήταν η «Μεταλλουργική εταιρεία Λαυρίου» γνωστότερη κι ως «Ελληνική Εταιρία» και η συνδρομή των μελών. Στεγάστηκε σε ιδιόκτητο κτήριο της «Ελληνικής Εταιρείας» που αποπερατώθηκε το 1896 γι’ αυτό το σκοπό.
Αρχιμουσικοί διετέλεσαν:
1897 – 1901: Κωνσταντίνος Γουβέλης (με τη συνδρομή του Ιωσήφ Καίσαρη)
1901 – 1903: Λεωνίδας Ραφαέλοβιτς, βοηθοί: Ιωάννης Κωστόπουλος & Σπυρίδων Μπέλικ, πατέρας του αρχ/κού Ανδρέα Μπέλικ
1903 – 1906: Νικόλαος Βλάχος, βοηθός: Σπυρίδων Μπέλικ
1906 – 1920: Σπυρίδων Μπέλικ, ενώ ο «Σύλλογος Φιλομούσων Λαυρίου» αντιμετωπίζει σοβαρά προβλήματα χρηματοδότησης απ’ την «Ελληνική Εταιρεία». Από το 1915 κι έπειτα, η μπάντα του συλλόγου περιόρισε σταδιακά τις εμφανίσεις της και το 1920 περίπου διαλύθηκε οριστικά.
Διακρίσεις:
Συμμετοχή στην Ολυμπιάδα της 25/10/1896 στην Αθήνα.
Συμμετοχή στη Μεσολυμπιάδα του 1906 στην Αθήνα, όπου στα πλαίσια διαγωνισμού έλαβε το Β’ Βραβείο.

[14]
Ο Ορέστης Αργυρόπουλος γεννήθηκε το 1888 στο Λαύριο και πέθανε το 1972 στην Αθήνα. Ήταν γιος του αρχίατρου της «Γαλλικής Εταιρείας Λαυρίου», προέδρου του Δημοτικού Συμβουλίου και εμπνευστή της Φιλαρμονικής Εταιρείας «Ευτέρπη» Νικόλαου Αργυρόπουλου και της Βικτωρίας Μπελαρντίνι.
Σπούδασε μεταλλειολογία στο Παρίσι (σύμφωνα με ορισμένες πηγές, στη Σχολή του Saint-Étienne) και το 1912 μπήκε στο Τεχνικό Επιμελητήριο. Μετά τις σπουδές του, εργάστηκε στα Μεταλλεία Λαυρίου ενώ από το 1949 έως 1951 διετέλεσε διευθυντής στον τομέα κατασκευών στα μεταλλεία. Έγραψε τουλάχιστον δύο σημαντικές μελέτες – εκθέσεις: «Έκθεσιςπερί των λευκολίθων της Ελλάδος (report on Greek magnesites)» εκδ.: ΙΓΜΕ, 1954 και «Έκθεσις περί των μεταλλοφόρων κοιτασμάτων του Λαυρίου (Cités métallifèresdu Laurium)» εκδ.: ΙΓΜΕ, 1965. Παράλληλα με τις σπουδές του ως μηχανικός – μεταλλειολόγος, ασχολήθηκε με τη μουσική και το πιάνο. Τα πρώτα μαθήματα τα πήρε από τη μητέρα του και στο Ωδείο Λόντερ στην Αθήνα, ενώ σπούδασε πιάνο με καθηγητές όπως η Λίζα Φρέτσα και ο Καρλ Μπέμερ. Αργότερα μελέτησε σύνθεση με τους Frank Choisy, Δημήτριο Λεβίδη και Μενέλαο Παλλάντιο.
Άφησε περίπου 15 έργα «εμπρεσιονιστικής» αλλά και «εξπρεσιονιστικής» υφής όπως: «6 Μπαγκατέλες» για πιάνο, 1918 αναθεώρηση 1945, «Τρίο» για έγχορδα, 1930 περίπου, «Andante» για ορχήστρα 1937, «Μικρή Σουίτα» για βιολί και πιάνο 1940 και σε μεταγραφή για ορχήστρα δωματίου 1944-1945, «Αφρικάνικες Εικόνες» για ορχήστρα 1947, «6 τραγούδια» για φωνή και ορχήστρα 1947-1948, «Σονάτα για πιάνο, σε κλασικό στυλ» 1958, «Πρελούδιο και Σκέρτσο» για πιάνο και για ορχήστρα 1947, κ.α. Θεωρείτε ιδιαίτερα προικισμένος συνθέτης ενώ τα έργα του, φαίνεται ότι διασώζονται σχεδόν όλα και βρίσκονται στο αρχείο του μουσικολόγου Γιάννη Γ. Παπαϊωάννου (1915-2000).
Ο Ορέστης Αργυρόπουλος το 1929 εξελέγη γερουσιαστής στην εκλογική περιφέρεια Αττικής / Βοιωτίας, με το Κόμμα των Φιλελευθέρων. Επίσης, είχε θητεία ως υποπρόξενος (προξενική θέση) του Βελγίου στο Λαύριο, ενώ τη περίοδο 1924 – 1930 διετέλεσε πρόεδρος του Δ.Σ. της Φιλαρμονικής Εταιρείας «Ευτέρπη».
Στη ζωή του, συνδύασε δύο πολύ διαφορετικές πορείες: τη μεταλλειολογία (με τεχνική, επιστημονική και διοικητική δράση στα μεταλλεία) και την τέχνη της μουσικής (ως πιανίστας και συνθέτης). Αυτό τον κάνει μια ασυνήθιστη «γέφυρα» ανάμεσα σε τεχνικά – βιομηχανικά και πολιτιστικά πεδία. Ο ρόλος του με τα μεταλλεία του Λαυρίου και οι μελέτες που συνέταξε, αποτελούν σημαντικό τεκμήριο της μεταλλευτικής ιστορίας της Ελλάδας και παρά το ότι η μουσική δεν ήταν το κύριο επάγγελμά του, κατάφερε να παράγει συνθετικό έργο με αξιώσεις και ν’ αφήσει ένα «συγκρατημένο αλλά ειλικρινές» αποτύπωμα στη νεοελληνική μουσική.
[15]
Στη πρώτη Ολυμπιάδα στην Αθήνα στις 25 Μαρτίου του 1896, συμμετείχαν οι μπάντες των Φιλαρμονικών εταιρειών και Συλλόγων: Κερκύρας (παλαιά), Κεφαλληνίας, Λευκάδος, Λαυρίου, Πύργου, Ζακύνθου, Πατρών, Αιγίου, και μια φιλαρμονική από την Κωνσταντινούπολη οι οποίες τοποθετήθηκαν από νωρίς πέριξ του σταδίου, παιανίζοντας κατά την άφιξη του κοινού, των επισήμων και κατά την είσοδο των αθλητών σε αυτό. Οι φιλαρμονικές στο τέλος εισήλθαν στο στάδιο παιανίζοντας από κοινού, καταλήγοντας στο κέντρο του στίβου και προκαλώντας δέος στους θεατές. Κάποιες εξ αυτών (όπως η Κερκυραϊκή) έδωσαν συναυλίες σε κεντρικά σημεία των Αθηνών την προηγούμενη μέρα και κατά τη διάρκεια των αγώνων.

Στην τελετή έναρξης, ο «Ολυμπιακός ύμνος» υπό τη διεύθυνση του ίδιου του Σπύρου Σαμάρα (του συνθέτη του ύμνου), εκτελέστηκε από σύμπραξη συμφωνικών ορχηστρών που σχημάτισαν η ορχήστρα της «Φιλαρμονικής εταιρείας των Αθηνών» με την ορχήστρα του «Συλλόγου Φιλομούσων των Αθηνών», από τις ορχήστρες πνευστών (μπάντες) της Στρατιωτικής Φρουράς Αθηνών, του Πυροβολικού και του Πολεμικού Ναυτικού και από τη μεγάλη χορωδία της «Φιλαρμονικής εταιρίας των Αθηνών», τις χορωδίες δύο μουσικών σωματείων από τον Πειραιά και τη χορωδία της Γερμανικής Λέσχης «Φιλαδέλφεια». Το σύνολο των μουσικών και χορωδών που πήρε θέση στο στίβο του σταδίου, ξεπερνούσε τα 300 άτομα.
Για τα παραπάνω στοιχεία μας πληροφορούν ο ίδιος ο Διονύσιος Λαυράγκας στα «Απομνημονεύματα» [εκδόσεις Γκοβόστη, 2009] σ.101-103, ως βοηθός του μουσουργού Σπύρου Σαμάρα, ο οποίος είχε αναλάβει τη σύνθεση του Ολυμπιακού Ύμνου έπειτα από ανάθεση της Ολυμπιακής Επιτροπής της εποχής. Ο Αντώνης Φίλιππας, στο βιβλίο του «Φιλαρμονική Λευκάδος, Ιστορική πορεία 135 χρόνων» [Αθήνα: Εταιρία Λευκαδικών μελετών, 1985] τ.Α’, σ.172. Ο Στέλιος Τζερμπίνος, στο βιβλίο του «Φιλαρμονικά Ζακύνθου» [Ζάκυνθος: Φιλόμουση Κίνηση Ζακύνθου, 1996] σ.65-68 και ο έγκριτος μουσικολόγος Σπύρος Μοτσενίγος, στο βιβλίο του «Νεοελληνική μουσική, Συμβολή εις την ιστορίαν της» [Αθήνα: 1958] σ. 334, με πηγή του την «Ιστορία της Νεοελληνικής Μουσικής» του Θ. Συναδινού.
Αξίζει να σημειωθεί πως πρόεδρος της Ολυμπιακής Επιτροπής του 1896, ήταν ο Φερδινάνδος (Φερνάνδος) Σερπιέρης, γιος του Ιωάννη Βαπτιστή Σερπιέρη που συνέχισε και επέκτεινε τις μεταλλευτικές και μεταλλουργικές δραστηριότητες της οικογένειας στο Λαύριο.
Χαρακτηριστικό είναι αυτό που διηγείτο ο αείμνηστος Νικόλαος Τζανετάκης (πατέρας των Λαυριωτών μουσικών κι αρχιμουσικών Μακάριου, Μιχάλη και Γεωργίου Τζανετάκη) ως μουσικός στην μπάντα του «Συλλόγου των Φιλομούσων» ενθυμούμενος: «… το 1896, όλες οι φιλαρμονικές που θα συμμετείχαν στην έναρξη, έκαναν πρόβα στο Παναθηναϊκό Στάδιο παίζοντας τον Ολυμπιακό Ύμνο. Ο μαέστρος Σάϊλερ κάποια στιγμή διέκοψε την εκτέλεση και παρατήρησε τον Ιταλό μουσικό Ρόμολο της φιλαρμονικής μας για ένα μικρό λάθος που έκανε. Αυτό επαναλήφθηκε για δεύτερη φορά, ο μαέστρος τον παρατήρησε έντονα και πήγε να ελέγξει τη παρτιτούρα, οπότε διαπίστωσε πως το λάθος δεν ήταν του δικού μας αλλά είχε γίνει λάθος στην αντιγραφή. Τότε δικαιωμένος ο Ρόμολο σηκώθηκε όρθιος και με την ιταλική προφορά του φώναξε δυνατά στους άλλους μουσικούς: «Άμα θέλετε να μάθετε καλά μουσική… ελάτε στο Λαύριο!»
[16]
Ο Βασίλης (Βάσος) Δασκαλάκης (1897-1944) στο βιβλίο του «Οι ξεριζωμένοι» (Αθήνα 1930) που περιγράφει με μυθιστορηματικό τρόπο τη ζωή των μεταλλωρύχων – μεταλλοτεχνικών του Λαυρίου, στις αρχές του 20ου αιώνα, μας πληροφορεί πως: η φιλαρμονική του «Συλλόγου Φιλομούσων Λαυρίου», εκτός της συμμετοχής της στην Ολυμπιάδα του 1896 στη Αθήνα, είχε πάρει μέρος σε μουσικούς αγώνες στην Ιταλία μαζί με άλλες φιλαρμονικές και είχε έρθει μεταξύ των πρώτων (βλ. 1) ενώ συμμετείχε, με αρχιμουσικό τον Νικόλαο Βλάχο και υπαρχιμουσικό τον Σπυρίδωνα Μπέλικ, στην Ολυμπιάδα του 1906 στο Παναθηναϊκό Στάδιο της Αθήνας και μάλιστα βραβεύτηκε (βλ. 2). Το πρώτο βραβείο, συνεχίζει ο Β. Δασκαλάκης, δόθηκε στη φιλαρμονική της Κέρκυρας «Άγιος Σπυρίδων» (βλ. 3) με αρχιμουσικό τον Π. Καραβάνα (βλ. 4) και στους «δικούς μας» το δεύτερο (βλ. 5). Οι Λαυριώτες, έμειναν με την εντύπωση ότι έχασαν τη πρωτιά λόγο της φτωχής τους εμφάνισης που σαφώς υστερούσε μπρος στις φανταχτερές και χρυσοστόλιστες στολές των Κερκυραίων με τα εντυπωσιακά λοφία στα καπέλα τους λέγοντας ότι… «τους έφαγαν τα λοφία»!
1) Το ταξίδι της φιλαρμονικής του «Σύλλογου Φιλομούσων Λαυρίου» στην Ιταλία για συμμετοχή σε μουσικούς αγώνες δεν έχει προς το παρόν, τεκμηριωθεί ιστορικά.
2) Λέγοντας «Ολυμπιάδα του 1906» ο Β. Δασκαλάκης, εννοεί την «Μεσολυμπιάδα του 1906» που έγινε στην Αθήνα από τις 22 Απριλίου έως τις 2 Μαΐου του 1906.
3) Με τη φράση Φιλαρμονική Κέρκυρας «Άγιος Σπυρίδων», ο Β. Δασκαλάκης προφανώς αναφέρεται στην «Φιλαρμονική Εταιρία Κερκύρας» (συντ.: ΦΕΚ) γνωστή κι ως «παλαιά φιλαρμονική» η οποία ιδρύθηκε το 1840 με σκοπό, μεταξύ άλλων, να συνοδεύει τις λιτανείες του Αγίου Σπυρίδωνα στην Κέρκυρα. Εκ του καταστατικού της μάλιστα «τίθεται υπό την προστασία του πάτρωνά της Αγίου Σπυρίδωνος, ομοίως και υπό την Σκέπην της Υπεραγίας Θεοτόκου». Αυτό τη συνέδεσε με την Εκκλησία και παλιότερα, την αποκαλούσαν ως «η μπάντα του Αγίου». Η οποία όμως, δεν αναφέρει τη συμμετοχή της στην «Ολυμπιάδα του 1906» στο ιστορικό της. Η ΦΕΚ είναι ένα από τα παλαιότερα μουσικά σωματεία στην Ελλάδα, με μεγάλη συμβολή στον πολιτιστικό και μουσικοεκπαιδευτικό χώρο και ανέκαθεν έδινε τη πρέπουσα σημασία στην ιστορία της. Θα ήταν απίθανο να της διαφύγει η καταγραφή της συμμετοχής της, σε ένα τόσο σπουδαίο γεγονός όπως μια «Ολυμπιάδα» στην οποία μάλιστα βραβεύτηκε.
*Η «Φιλαρμονική Εταιρεία Λευκάδος» (συντ.: ΦΕΛ), η οποία ιδρύθηκε το 1850, με σημαντική συμβολή στο χώρο, που συμμετείχε στην «Ολυμπιάδα του 1906» και το αναφέρει λεπτομερώς στο ιστορικό της, μας λέει πως ήταν η μοναδική Επτανησιακή Φιλαρμονική.
4) Ο Πέτρος Καραβάνας (1867-1918) ήταν Κερκυραίος συνθέτης, αρχιμουσικός και μουσικοπαιδαγωγός, το 1903 ως το 1918, διατέλεσε αρχιμουσικός της Φιλαρμονικής Εταιρείας Κερκύρας και συνέβαλλε κατά πολύ στην ανάδειξή της.
5) Στην «Ολυμπιάδα του 1906» είναι γνωστό πως προσκλήθηκαν όλες οι Φιλαρμονικές Εταιρείες που συμμετείχαν στην Ολυμπιάδα του 1896, μεταξύ των οποίων και του Λαυρίου. Δε μπόρεσαν να πάνε όλες τελικά λόγω οικονομικών προβλημάτων και πιθανών να δόθηκαν κάποια αναμνηστικά βραβεία ως ευχαριστήρια συμμετοχής σε όποιες πήγαν, αλλά κάποιος μουσικός διαγωνισμός φιλαρμονικών με βραβεύσεις (εφόσον γίνεται λόγος για Α’ & Β’ βραβείο) δεν έχει ιστορικά καταγραφεί.
*Δημοσιεύματα τύπου (εφ. Σκριπ. 11/4/1906) που περιγράφουν τα γεγονότα της εποχής, αναφέρουν μόνο τις φιλαρμονικές Σύρου, Λευκάδος, Αθηνών και Μοναστηρίου, το ίδιο και η ΦΕΛ στο ιστορικό της.
Ως συμπέρασμα: Ο Β. Δασκαλάκης, δίνει κάποια πραγματικά στοιχεία για κάτι που δε μπορεί να θεωρηθεί μύθευμα (Άγιος Σπυρίδωνας, λοφία, Π. Καραβάνας) αλλά λοιπά στοιχεία και καταγραφές δε το τεκμηριώνουν ως γεγονός. Σίγουρα κάτι έγινε μια που η «βράβευση» της μπάντας, ήταν ένα σπουδαίο γεγονός για το Λαύριο, ίσως όχι στα πλαίσια της Ολυμπιάδας. Η συμμετοχή της μπάντας του «Συλλόγου Φιλομούσων Λαυρίου» στην «Ολυμπιάδα του 1906» καθώς και η βράβευσή της είναι κάτι που θα πρέπει να ερευνηθεί και να τεκμηριωθεί περαιτέρω.
Αντίστοιχα, η μπάντα της Φιλαρμονικής Εταιρείας «Ευτέρπη» συμμετείχε σε μουσικούς αγώνες στο Παναθηναϊκό στάδιο της Αθήνας το 1900 ή 1901 στα πλαίσια των «Μεγάλων Γυμναστικών Επιδείξεων» και των «Πανελλήνιων Αγώνων» φέρνοντας στην πόλη το Β’ βραβείο. Ανάλογη διάκριση στους ίδιους αγώνες είχε και η «Μπάντα του Ορφανοτροφείου Χατζηκώνστα». Οι αγώνες αυτοί, δεν είχαν μόνο αθλητικό χαρακτήρα αλλά προβάλλονταν από τον τύπο της εποχής ως μέσο συγκρότησης της εθνικής ταυτότητας και ως παιδαγωγικό εργαλείο, ενώ η συμμετοχή φιλαρμονικών κυρίως από την επαρχία (όπως του Λαυρίου) υπογράμμιζε τη διάδοση της λόγιας μουσικής στα αστικά κέντρα της Ελλάδος στα τέλη του 19ου αιώνα.
Μουσικοί αγώνες (διαγωνισμοί) μεταξύ φιλαρμονικών στο Παναθηναϊκό Στάδιο, αποτελούσαν σημαντικό πολιτιστικό γεγονός της παλιάς Αθήνας στα τέλη του 19ου και στις αρχές του 20ου αιώνα κι ήταν άρρηκτα συνδεδεμένοι με τους «Σχολικούς και Γυμναστικούς αγώνες», κυρίως μετά την αναβίωση των Ολυμπιακών αγώνων του 1896, όπου η συγκέντρωση πολλών προσκεκλημένων φιλαρμονικών είχε προκαλέσει δέος. Το «Καλλιμάρμαρο» καθιερώθηκε ως ο κατεξοχήν χώρος για τέτοιες διοργανώσεις λόγο της ακουστικής του και της χωρητικότητάς του.

[17]
Μεσολυμπιάδα του 1906. Επρόκειτο για τους Μεσοολυμπιακούς Αγώνες του 1906 ή ανεπίσημα γνωστοί κι ως Ολυμπιακοί Αγώνες του 1906. Ήταν διεθνής αθλητική διοργάνωση, η οποία διεξήχθη από τις 22 Απριλίου έως τις 2 Μαΐου του 1906 στην Αθήνα.
Οι αγώνες αυτοί δεν έχουν το τίτλο της Ολυμπιάδας, αφού το 1906 δεν ήταν επίσημη Ολυμπιακή χρονιά, παρά το γεγονός ότι στα περισσότερα έντυπα της εποχής αναφέρονταν ως Ολυμπιακοί Αγώνες. Στους νικητές δόθηκαν μετάλλια, που όμως δεν καταμετρώνται επίσημα από τη Διεθνή Ολυμπιακή Επιτροπή.
Επρόκειτο για ένα θεσμό που προέκυψε μετά από αίτημα της Ελλάδας να διοργανώνονται μόνιμα αγώνες στην Αθήνα, στο μεσοδιάστημα δύο διαδοχικών Ολυμπιακών διοργανώσεων (μεσολυμπιάδα), κάτι που τελικά, δε τελεσφόρησε. Ήταν οι αγώνες που έγιναν για πρώτη και τελευταία φορά!
Η Μεσολυμπιάδα του 1906 διήρκησε 11 μέρες με τη συμμετοχή 884 αθλητών από 20 χώρες. Για πρώτη φορά οι αθλητές που έπαιρναν μέρος ήταν εγγεγραμμένοι μέσω των εθνικών ολυμπιακών επιτροπών. Στην τελετή έναρξης, η είσοδος των αθλητών έγινε υπό τη σημαία κάθε χώρας ενώ στην τελετή λήξης έγινε για πρώτη φορά έπαρση της σημαίας για τους νικητές. Οι αθλητές διέμεναν στο Ζάππειο, που αποτέλεσε τον πρόγονο του Ολυμπιακού Χωριού.
Ο κ. Αριστείδης Κανατούρης, στην ομιλία του στο Λαύριο για την παρουσίαση του Λευκώματος 2017 της Χορωδίας Λαυρίου, περιγράφει:

[19]

[20]

[21]

[22]
Η λέξη «διάνα» είναι ένα επίρρημα που εκφράζει συνήθως την απόλυτη επιτυχία, την επίτευξη ενός σκοπού ή στόχου πχ «πέτυχα διάνα» κλπ. Όμως, σύμφωνα με το Λευκαδίτικο γλωσσικό ιδίωμα η ίδια λέξη, θα πει και «εωθινός», «εωθινός ύμνος» δηλ.: πρωινό τραγούδι, ή πρωινή προσευχή, με το πρώτο φως της ημέρας! Μ’ αυτή την έννοια λοιπόν, η «Διάνα», είναι ένα πρωτοχρονιάτικο έθιμο που βρίσκουμε στη Λευκάδα, πιθανών απ’ την εποχή της Ενετοκρατίας ή της Αγγλικής αρμοστείας των Επτανήσων πολύ πριν την ένωσή τους με την Ελλάδα το 1864.
Σύμφωνα με τον Αντώνη Φίλιππα λοιπόν, στο βιβλίο του: «Ιστορία της Φιλαρμονικής Λευκάδας» [εταιρεία Λευκαδίτικων Μελετών, έκδ.: 1985] «ανήμερα την Πρωτοχρονιά, πολύ πριν ξημερώσει (από τον όρθρο) η Φιλαρμονική τριγυρίζει στην πόλη παίζοντας χαρμόσυνα κομμάτια. Στο άκουσμα της μπάντας, πολλοί από τους κατοίκους της πόλεως, κυρίως νέοι και νέες, έβγαιναν απ’ τα σπίτια τους (ως συνέχεια της πρωτοχρονιάτικης μάζωξης) και την ακολουθούσαν τραγουδώντας μαζί της για την νέα χρονιά! Με τα χρόνια όμως, την ακολουθούσαν «αλαλάζοντας και θορυβώντας ατάκτως και εν πλήρει ελευθερία». Με φωνές, τραγούδια, σφυρίχτρες, καραμούζες κι άλλα παρόμοια. Γίνονταν σωστό πανδαιμόνιο που μάλιστα, δεν περιορίζονταν πάντα σε αβλαβείς και γιορτινές εκδηλώσεις. Έτσι πολλοί θεώρησαν το έθιμο βάρβαρο και σταδιακά καταργήθηκε. Στις μέρες μας βγαίνει μόνο η μπάντα κι όχι τόσο πρωί αλλά μετά το ξημέρωμα. Δεν υπάρχουν στοιχεία του συγκεκριμένου εθίμου της «Λευκαδίτικης Πρωτοχρονιάτικης Διάνας» σε άλλα μέρη της Ελλάδας (ούτε καν στα υπόλοιπα Επτάνησα).
Στις μπάντες των μεγάλων πόλεων, οι ερασιτεχνικές μα κυρίως οι στρατιωτικές ή οι ελάχιστες επαγγελματικές, ήταν συνηθισμένο παλιότερα, σε μεγάλες Εθνικές ή Θρησκευτικές εορτές αλλά και τη Πρωτοχρονιά (πλην της Μεγάλης Παρασκευής) να κάνουν το λεγόμενο «Εωθινών». Δηλαδή: Να παιανίζουν εορταστικά εμβατήρια νωρίς το πρωί στους δρόμους της πόλεως «πηγαίνοντας» προς το σημείο (χώρο) της παράταξης. Στις μέρες μας αυτό είναι σχεδόν αδύνατο λόγω των αποστάσεων αλλά σε μικρότερες πόλεις, κυρίως επαρχιακές που οι αποστάσεις μπορούν να καλυφθούν περπατώντας, με βηματισμό εμβατηρίου και παιανίζοντας, το «Εωθινών» γίνεται!
Γύρω στο 1860 ο Ελληνοβαυαρός αρχιμουσικός Ανδρέας Ζάϊλ(λ)ερ κι όχι Σάϊλερ όπως λανθασμένα έχει επικρατήσει (1830-1903) συνέθεσε ένα μικρό κι ευέλικτο εμβατήριο γι’ αυτό το σκοπό «το Εωθινόν Εμβατήριο» (το πρωινό δηλ., το βρίσκουμε κι ως «Εγερτήριων») το οποίο δεν είναι αποκλειστικά και μόνο για το πρωί της πρωτοχρονιάς. Σε πολλές περιοχές (που οι τοπικές επαρχιακές μπάντες μπορούν να κάνουν ακόμα Εωθινών) παίζεται, κυρίως στις Εθνικές Επετείους. Ο Ανδρέας Ζάϊλερ ήταν γιός του Βαυαρού αρχιμουσικού Φράντς Ζάϊλερ ο οποίος σαν στρατιωτικός μουσικός είχε ακολουθήσει τον βασιλιά Όθωνα στην Ελλάδα κι «οργάνωσε» σταδιακά (όπως ο Αυστριακός αρχιμουσικός Michael Mangel) τις Ελληνικές στρατιωτικές φιλαρμονικές. Ο Ανδρέας γεννημένος στην Ελλάδα δεν έχει γνωρίσει την Βαυαρία, μιλάει άπταιστα Ελληνικά και αγαπάει την Ελλάδα περισσότερο ίσως και από άλλους Έλληνες της εποχής του, εξελίχθηκε σε έναν ικανότατο αρχιμουσικό και συνθέτη μαθητεύοντας κυρίως κοντά στον πατέρα του, ενώ ασπάζεται την ορθοδοξία και κατατάσσεται στο Πυροβολικό του Ελληνικού Στρατού. Το εμβατήριο «Μαύρη είναι η νύχτα στα βουνά» και το εμβατήριο «Σημαία» (που στις μέρες μας παιανίζετε για απόδοση τιμών στη σημαία και σε επισήμους) όπως και το πασίγνωστο τραγούδι «Μπάρμπα Γιάννης κανατάς» είναι δικές του συνθέσεις. Μετά την αποστράτευσή του αναλαμβάνει εταιρικές μπάντες όπως τη «Φιλαρμονική εταιρεία των Αθηνών», τη «Φιλαρμονική Πειραιώς» και τη «Φιλαρμονική εταιρεία Λευκάδος».
Τον Ζάϊλερ στη Λευκάδα τον διαδέχεται ένας άλλος ικανότατος αρχιμουσικός, ο Ιταλός Φραντζέσκο Νικολίνι (Francesco Nicollini), που διατέλεσε αρχιμουσικός εκεί ενώ στο τέλος του 19ου αιώνα ήρθε στο Λαύριο για ν’ αναλάβει τη μπάντα της «Φιλαρμονικής Εταιρείας Ευτέρπη». Μαζί του, όπως ήταν επόμενο, ήρθε και στο Λαύριο το έθιμο της Πρωτοχρονιάτικης «Διάνας» που σε συνδυασμό με το εμβατήριο του Ζάϊλερ, το «Εωθινόν», σταδιακά πέρασε στη συνείδηση των μουσικών και της πόλης ως γιορτινή – πρωτοχρονιάτικη μουσική.

Έκτοτε, το έθιμο της «Διάνας» γίνεται και στο Λαύριο με μέλη της φιλαρμονικής του Δήμου, να ξεκινούν από της 04:00 με 05:00 τα ξημερώματα της πρωτοχρονιάς παίζοντας το «Εωθινόν» στους δρόμους της πόλης, εκπλήσσοντας συνήθως τους επισκέπτες και ξυπνώντας ευχάριστα τους ντόπιους.
Ο λόγος του πρωινού ξυπνήματος μας έρχεται από την προπολεμική εποχή όταν οι μπάντες των μεταλλουργικών εταιριών, έπρεπε να τελειώσουν με τη «Διάνα» στο Λαύριο αρκετά νωρίς, ώστε να επιβιβαστούν σε… φορτηγά που θα τους μετέφεραν στην ευρύτερη περιοχή των Μεσογείων για να παίξουν το «Εωθινόν» κι εκεί.
[23]
Ο Καλλιτεχνικός Μουσικός Σύλλογος Λαυρίου «Αρίων» συστάθηκε το 1929, αν και αναγνωρίστηκε στης 27/8/1931 με την απ’ αριθ. 7817 Απόφαση του Πρωτοδικείου Αθηνών. Σύμφωνα με το άρθρο 2 του Καταστατικού του, σκοπός του Συλλόγου ήταν η μουσική εκπαίδευση των μελών του και η τόνωση του «μουσικού συναισθήματος» των κατοίκων του Λαυρίου. Ο πραγματικός στόχος όμως, ήταν να καλύψει το καλλιτεχνικό κενό που δημιουργήθηκε, έπειτα από τη διάλυση του «Συλλόγου Φιλομούσων Λαυρίου» το 1920 και τη διακοπή της λειτουργίας της «Ευτέρπης» το 1929-1930 εξαιτίας οικονομικών προβλημάτων.
Ο Σύλλογος διοικούταν από Δ.Σ. (αιρετό Διοικητικό Συμβούλιο) και συντηρούνταν αποκλειστικά από τα μέλη του. Η ομώνυμη μπάντα του, στελεχώθηκε από μουσικούς των φιλαρμονικών που «έκλεισαν».
Αρχιμουσικοί διετέλεσαν:
1929 – 1930: Κωνσταντίνος Ρούσσος
1930 – 1933: Σταδιακή διακοπή της λειτουργείας της μπάντας, με την επαναλειτουργία της «Ευτέρπης» οι περισσότεροι μουσικοί του «Αρίων» επέστρεψαν στην Φιλαρμονική της «Ευτέρπης».
1933 – ;: Αθανάσιος Πισσάνος, προσπάθεια ανασύστασης της σχολής της φιλαρμονικής.
; – 1939: Εμμανουήλ Τσόρης, η φιλαρμονική της «Ευτέρπης» με την επαναλειτουργία της το 1930, απορρόφησε σταδιακά σχεδόν όλους τους μουσικούς και τους μαθητές του «Αρίων», με αποτέλεσμα την οριστική διάλυση του συλλόγου.

Χαρακτηριστικό ήταν πως η μπάντα του «Αρίων» δε πρόλαβε να φτιάξει στολές, φορούσε μόνο πηλίκια!
[24]
Ο Μάνος Χατζιδάκις προόριζε τη μουσική αρχικά για τη ταινία «Τόπ Καπί» (1963-1964) αλλά τελικά τραγουδήθηκε σε στίχους του Νίκου Γκάτσου το 1965 από τον Γρηγόρη Μπιθικώτση ο οποίος, εκτός του ότι υπηρέτησε ως φρουρός στην Μακρόνησο, είχε και οικογενειακούς δεσμούς με τη πόλη μια που η σύζυγός του Θεοκλεία καταγόταν απ’ το Λαύριο.
Το τραγούδι τελικά κυκλοφόρησε σε ένα δίσκο 45RPM της ODEON [CGRA 2782] και όπως μας πληροφορεί ο Λαυριώτης στιχουργός Χρήστος Προμοίρας, αναφέρεται στο κτίριο «Ευτέρπη» που στις δεκαετίες του 1950 και 1960 αλλά και πολύ παλιότερα, χρησιμοποιούνταν για χορούς. Στη διάρκεια του Εμφυλίου όμως, ήταν στρατοδικείο όπου καταδικάζονταν αγωνιστές και στέλνονταν στη Μακρόνησο, στην οποία φαίνεται να παραπέμπουν οι στίχοι του Νίκου Γκάτσου.
Έριξα πέτρα στο πηγάδι, για να βρω νερό,
ένα χρυσό φλουρί στον Άδη και σε καρτερώ.
Ποιος είν’ απόψε ο τυχερός, στο Λαύριο γίνεται χορός!
Στο Λαύριο γίνεται χορός, ποιος είν’ απόψε ο τυχερός!
Κράτησα δίκοπο μαχαίρι στον πικρό καιρό
κι είπα στη νύχτα να σε φέρει και σε καρτερώ.
Ποιος είν’ απόψε ο τυχερός, στο Λαύριο γίνεται χορός!
Στο Λαύριο γίνεται χορός, ποιος είν’ απόψε ο τυχερός!
Έριξα πέτρα στο πηγάδι …
Ποιος είν’ απόψε ο τυχερός …
Οι στίχοι όπως ήταν αναμενόμενο, λογοκρίθηκαν αγρίως από τη χούντα. Βαριά κουβέντα το «κράτησα δίκοπο μαχαίρι στον πικρό καιρό» βλέπεις, κι έτσι ο Γκάτσος αναγκάστηκε να τους αλλάξει «κρύβοντας» με την περίσσια τέχνη του τα νοήματα των στίχων του απ’ τους λογοκριτές.
Έριξα πέτρα στο πηγάδι για να βρω νερό,
ένα χρυσό φλουρί στον Άδη και σε καρτερώ!
Δεν έχω ελπίδα να χαρώ, τη χάρη σου μεσ το χορό!
Ποιος είν’ απόψε ο τυχερός; στο Λαύριο γίνεται χορός.
Ποιος είν’ απόψε ο τυχερός; στο Λαύριο γίνεται χορός.
Ψυχή στο βράχο καρφωμένη με εφτά καρφιά.
Μπόρα πικρή σε περιμένει και μια συννεφιά.
Εφτά καρφιά εφτά παιδιά μου ‘χουν ματώσει την καρδιά.
Ποιος είν’ απόψε ο τυχερός; στο Λαύριο γίνεται χορός.
Ποιος είν’ απόψε ο τυχερός; στο Λαύριο γίνεται χορός.
Μια σπίθα ανάβει, μέσα απ’ τη σβησμένη πυρκαγιά.
Κι είναι κερί που καίει τη νύχτα μπρος στην Παναγιά.
Ποιος είν’ απόψε ο τυχερός; στο Λαύριο γίνεται χορός.
Ποιος είν’ απόψε ο τυχερός; στο Λαύριο γίνεται χορός.
Το τραγούδι ηχογραφήθηκε με τους νέους στίχους, απ’ την Νανά Μούσχουρη το 1966, απ’ τους Μαρία Δουράκη και Γιώργο Μούτσιο το 1970, το έχουμε σε δύο ορχηστρικές εκδοχές, με τον Γιώργο Ζαμπέτα το 1965 και του ίδιου του Χατζιδάκι στα «30 Νυχτερινά» του 1983, ενώ το 1993 στην ηχογράφηση του CD «Η Μελίνα του Μάνου στο Σείριο» ο συνθέτης παίζοντας πιάνο το τραγουδάει, για να το μάθει η Μελίνα Μερκούρη.
Ένα χρόνο μετά, ταξίδεψαν κι οι δύο για τ’ αστέρια…
Πηγές
- Α. Γ. Κανατούρη: Προσωπικό αρχείο (δημοσιεύματα, αναφορές τύπου, ΦΕΚ)
- Α. Γ. Κανατούρη: Ομιλία στη παρουσίαση Λευκώματος «Ευτέρπη» της Χορωδίας Λαυρίου, 2007
- Α. Γ. Κανατούρη: Η Προξενική εκπροσώπηση στο Λαύριο 1874-1940 (Εταιρία Μελετών ΝΑ. Αττικής)
- Χ. Συρίγου: Προσωπικό φωτογραφικό αρχείο
- Ιγν. Χατζηγνατιάδη: Προσωπικό φωτογραφικό αρχείο
- Εμ. Μπαλόπιτα: Προσωπικό φωτογραφικό αρχείο
- Εμ. Μαρκουλή: Προσωπικό αρχείο
- Ηλία Κονοφάγου: Προσωπικό αρχείο
- Οικογένεια Ζάρμπ: Προσωπικό αρχείο
- Κ. Μαυριδερού: Προσωπικό αρχείο
- Κ. Γ. Μάνθου: Προσωπικό αρχείο
- Γ. Κ. Μάνθου: Οι φιλαρμονικές του Λαυρίου (μελέτη)
- Σπ. Μοντσενίγου: Νεοελληνική Μουσική (Αθήνα, 1958)
- Β. Δασκαλάκη: Οι ξεριζωμένοι (Αθήνα, 1930)
- Α. Τρασουλέα: Ολυμπιάδες στην Αθήνα 1896-1906 (Αθήνα, 1988)
- Γ. Δερμάτη – Τοπία και μνημεία της Λαυρεωτικής (εκδ.: Δήμος Λαυρωτικής,1994)
- Τ. Καλογερόπουλου: Λεξικό της Ελληνικής μουσικής (εκδ. Γιαλλελή, 2001)
- Α. Τρικούπη: Western Music in Hellenic Communities Musicians and Institutions (Αθήνα, 2015)
- Γ. Α. Πέππα: Τα σωματεία του Λαυρίου (Ε.ΜΕ.Λ., 2016)
- Β. Κιούση – Ι. Γ. Λυμπέρη: Συνδιαμορφωτικοί παράγοντες του αστικού πολιτισμού και της μουσικής ταυτότητας: Η Δημοτική Φιλαρμονική της πόλης του Λαυρίου (Αθήνα, 2019)
- Έκθεσις Δ.Σ. και Ελεγκτικής Επιτροπής του Συλλόγου Φιλομούσων Λαυρίου, έτους 1905
- Μαρτυρίες παλαιών μελών των φιλαρμονικών Λαυρίου (αρχιμουσικών & μουσικών)
- Δήμος Λαυρεωτικής
- Ελληνικός Ορυκτός Πλούτος – Μεταλλεία Λαυρίου, Λαυρεωτικό ζήτημα – https://www.oryktosploutos.net/
- Τεχνολογικό πάρκο Λαυρίου – https://www.ltcp.ntua.gr/history/
Ευχαριστούμε τους Αριστείδη Κανατούρη για τη διάθεση των τεκμηριωμένων στοιχείων και Χαράλαμπο Συρίγο για τη διάθεση και την επιμέλεια των φωτογραφιών.
Για τον Σύλλογο Φίλων Δημοτικής Φιλαρμονικής Λαυρίου «Γιάννης Γλαντζής», Αλέξανδρος Κάτσιος, Λαύριο 2026







































